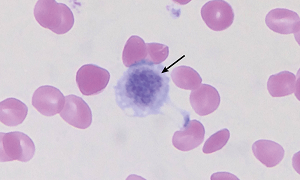
Macrothrombocytopenia

Blood Platelets in Cavaliers:
Blood Platelets in Cavaliers:
Too Few (Thrombocytopenia) and
Too Large (Macrothrombocytopenia)
Are Usually Not a Serious Health Disorder
-
 IN SHORT
IN SHORT - IN DEPTH
- Details About This Benign Disorder
- Symptoms
- • not immune thrombocytopenia (ITP)
- • not immune-mediated hemolytic anemia (IMHA)
- Platelet Counting Procedures
- • automated and manual methods
- • plateletcrit method
- DNA Testing
- Treatment
- Research Studies' Findings
- • platelet size and counting issues
- • possible relationship with other disorders
- What You Can Do
- Research News
- Related Links
- Veterinary Resources
IN SHORT
Over half of all cavalier King Charles spaniels may have both an abnormally low number of platelets and also have oversized platelets in their blood. This benign condition is called idiopathic asymptomatic thrombocytopenia and is normal in cavaliers, requiring no treatment.
 Platelets usually
are the smallest cells in the blood system. They serve to bind together and clot
when they come in contact with a damaged blood vessel.
Despite the low platelet
counts, the typical cavalier's blood platelets function normally, and the dog
does not appear to experience any health problems due to either the size or
fewer numbers of its platelets. There are, however, exceptions to this typical
situation.
Platelets usually
are the smallest cells in the blood system. They serve to bind together and clot
when they come in contact with a damaged blood vessel.
Despite the low platelet
counts, the typical cavalier's blood platelets function normally, and the dog
does not appear to experience any health problems due to either the size or
fewer numbers of its platelets. There are, however, exceptions to this typical
situation.
Excessively low platelet counts normally is a sign which tends to alarm general practice veterinarians, and so it is vitally important that cavalier owners alert their vets about this benign condition in the breed when blood tests are ordered. More...
RETURN TO TOP
 IN DEPTH
IN DEPTH
Platelets, also called thrombocytes, are blood cells which control blood clotting, to stop bleeding at open wounds. They clump together and clot when they come in contact with a damaged blood vessel, to seal it and prevent the loss of blood. Platelets are produced in the bone marrow. They are very complex cell fragments, containing a variety of components, most of which serve to stop bleeding (hemostasis). (See diagram at right.)
More than half of all cavalier King Charles spaniels may have both an abnormally low
number of blood platelets
 and
also have oversized platelets.*
In most breeds, platelets are usually the smallest cells in the blood system.
(See diagram above.) In the
CKCS, however, the oversized platelets (called macrothrombocytes) are
equal to or larger than a red blood cell.
and
also have oversized platelets.*
In most breeds, platelets are usually the smallest cells in the blood system.
(See diagram above.) In the
CKCS, however, the oversized platelets (called macrothrombocytes) are
equal to or larger than a red blood cell.
Despite the low platelet counts, the typical cavalier's blood platelets function normally, and the dog does not appear to experience any health problems due to either the smaller size or fewer numbers of its platelets. There are, however, limited exceptions to this typical situation. See this section of this webpage.
*Other breeds reported to have similar conditions include the Japanese Akita, Cairn terrier, and Norfolk terrier.croplatelets
An excessively low platelet count normally is a sign which tends to alarm general practice veterinarians, and so it is vitally important that cavalier owners alert their vets about this benign condition in the breed when blood tests are ordered.
No treatment is recommended unless the dog shows other symptoms of a blood-related disorder. Cavaliers should not be treated for immune-mediated thrombocytopenia (IMT) as a precaution. A dog really suffering from IMT must be treated quickly, usually with intravenous doses of immunosuppressive drugs -- steroids, azathioprine, cyclosporine A, and others -- to save the dog's life. Such treatments are severe and could do major damage to the healthy cavalier with nothing more than a low platelet count.
Most commercial laboratories use an automated counting system for blood cells, which determine cell types on the basis of their size and volume. Because some of cavaliers' platelets are so large, automated blood cell counters may not recognize platelets as being platelets and undercount them (thinking they are the typically larger red blood cells), thereby inaccurately lowering the platelet count. Researchers have found that CKCS platelet counts using three different automated systems underestimated the actual counts determined manually. Antech Diagnostics, the largest veterinary diagnostic laboratory, has specifically stated on its website that:
"Platelets in this breed should be counted manually, because automated blood cell counters cannot distinguish the large platelets from erythrocytes and therefore underestimate the true platelet count."
An accurate platelet count usually can be obtained by visually counting the cells. Also, because the large platelets are so fragile, any blood samples should be extracted very carefully. Therefore, all blood samples from cavaliers should be taken in a very careful manner and preferably only from the dog's jugular vein, using a large bore needle, and then should be examined only under a microscope by an experienced clinical pathologist before making a diagnosis of low platelet count.
RETURN TO TOP
Details About This Benign Disoder
Blood platelets (also called thrombocytes) are disk-shaped blood elements which aid in blood clotting. Platelets customarily are individually counted to determine whether dogs suffer from platelet disorders. Excessively low numbers are called thrombocytopenia and are the most common cause of bleeding disorders in dogs.
As many as half of all cavalier King Charles spaniels may have a congenital blood disorder called idiopathic asymptomatic thrombocytopenia, which means an abnormally low number of blood platelets but with no bleeding consequences, according to several studies. We say "may" because a 2008 Swedish study has found no thrombocytopenia in 27 CKCS when their blood was tested on a device using the plateletcrit method which measures platelet volume rather than numbers of platelets.
 The platelets in the blood of many cavalier King Charles spaniels are a
combination of those of normal size for dogs and others that are abnormally
oversized. Cavaliers' oversized platelets are called macrothrombocytes.
(See oversized CKCS platelet in blood smear at right.*) Macrothrombocytosis also is a congenital abnormality found in at least a third
of CKCSs.
The platelets in the blood of many cavalier King Charles spaniels are a
combination of those of normal size for dogs and others that are abnormally
oversized. Cavaliers' oversized platelets are called macrothrombocytes.
(See oversized CKCS platelet in blood smear at right.*) Macrothrombocytosis also is a congenital abnormality found in at least a third
of CKCSs.
*Courtesy, Jessica Anne Kelley master's thesis, Univ. Minn.
These large platelets function normally, and the typical cavalier does not appear to experience any health problems due to either the size or fewer numbers of its platelets. The theory of the 2008 Swedish study is that there appears to be an inverse relationship between platelet count and platelet size. This means that lower numbers of large platelets represent the same overall platelet mass as higher numbers of small platelets.
There are, however, exceptions to this typical situation. A June 2010 study has confirmed that "The data supports previous findings that CKCS with macrothrombocytopenia have a normal coagulation response despite low platelet counts."
Nevertheless, researchers hypothesize that cavaliers' giant platelets are the source of high levels of serotonin which may contribute to mitral valve disease in the breed. Read the details here.
In an April 2004 article, the Danish cardiologists found no relation between thrombocytopenia and femoral (hind leg) artery pulse strength in the 109 cavaliers in that study.
In a July 2015 article, the same benign disorder also has been reported, to a lesser extent, in other breeds, including Norfolk and Cairn terriers, Chihuahuas, Labrador retrievers, poodles, English toy spaniels (King Charles spaniels), shih tzus, Maltese, Jack Russell terriers, Havanese, boxers, cocker spaniels, bichons frises, and some mixed breeds.
RETURN TO TOP
Symptoms
The typical CKCS with idiopathic asymptomatic thrombocytopenia does not appear to experience any health problems due to either the size or fewer numbers of its platelets. Nevertheless. many veterinarians have mis-diagnosed this benign disorder with either immune-mediated thrombocytopenia (IMT) or immune-mediated homolytic anemia (IMHA). However, in one reported case, in a November 2021 article, a cavalier correctly diagnosed with IMT and IMHA initially was thought to have only macro-platelets and not IMT.
• It is NOT immune thrombocytopenia (ITP)
However, many veterinarians who are ignorant about the cavaliers' benign disorder hurriedly conclude that the dog is suffering from immune thrombocytopenia (ITP), or immune mediated thrombocytopenia (IMT), which is a very serious autoimmune disease in which the dog's body attacks its own blood platelets as though they are a pathogenic bacteria or virus.
 IMT
also has some very serious symptoms, such as an unusual susceptibility to
bleeding (hemorrhaging), petechiae (pinpoint
bruising -- small [<3 mm.] red or purple spots on the dog, caused by broken capillary blood vessels
-- see photo at left),
IMT
also has some very serious symptoms, such as an unusual susceptibility to
bleeding (hemorrhaging), petechiae (pinpoint
bruising -- small [<3 mm.] red or purple spots on the dog, caused by broken capillary blood vessels
-- see photo at left),
 ecchymosis (larger bruising), bleeding from the mouth or nose
or within the eye
(see photo at right), pale gums, bloody urine, lethargy, weakness,
an abnormally rapid heart rate, rapid beathing, and/or melana
(dark, tarry stools that indicate the
presence of blood in the GI tract). See this
September 2015 article for more information about IMT. It may also be
referred to as Evans Syndrome. Heatstroke may
result in similar distressing symptoms. So, unless the CKCS also has any of
those symptoms, it is extremely likely that all the cavalier has is the breed's
benign platelet disorder.
ecchymosis (larger bruising), bleeding from the mouth or nose
or within the eye
(see photo at right), pale gums, bloody urine, lethargy, weakness,
an abnormally rapid heart rate, rapid beathing, and/or melana
(dark, tarry stools that indicate the
presence of blood in the GI tract). See this
September 2015 article for more information about IMT. It may also be
referred to as Evans Syndrome. Heatstroke may
result in similar distressing symptoms. So, unless the CKCS also has any of
those symptoms, it is extremely likely that all the cavalier has is the breed's
benign platelet disorder.
See this May 2024 ACVIM Consensus Statement on ITP.
• It is NOT immune-mediated hemolytic anemia (IMHA)
Another auto-immune disease in some cases confused with idiopathic asymptomatic thrombocytopenia is immune mediated hemolytic anemia (IMHA), in which the dog's body attacks its own red blood cells, leading to low red blood cell counts and requiring blood transfusions.
• It is NOT severe fever with thrombocytopenia (SFTS) virus
Severe fever with thrombocytopenia syndrome (SFTS) is a tick-borne zoonotic virus with symptoms which include low platelet counts, due to the virus attaching to the dog's platelets in the spleen. While symptoms commonly include platelet counts below the reference range, invariably there are other symptoms, such as 9as its name implies) fever, anorexia, depression, vomiting, and diarrhea. See this April 2022 article.
RETURN TO TOP
Platelet Counting Procedures
• automated and manual disorders
Most commercial laboratories use an automated counting system for blood
cells, which determine cell types on the basis of their size and volume. Because
some of cavaliers' platelets are so large, automated blood cell counters may not
recognize platelets as being platelets (treating them as if they were the larger
red blood cells) and undercount them, thereby inaccurately
lowering the platelet count. In a 2004 Danish study and the
2007 Italian study,
the researchers found that all of their CKCS platelet counts using three
different automated systems underestimated the actual counts determined
manually. Antech Diagnostics, the largest veterinary diagnostic laboratory,
specifically states on its website that "Platelets in this breed should be
counted manually, because automated blood cell counters cannot distinguish the
large platelets from erythrocytes [red blood cells] and therefore underestimate the true platelet
count." In some cases, false counts of platelets by automated blood
analyzers has been referred to as "Pseudothrombocytopenia"
(PTCP).
Most commercial laboratories use an automated counting system for blood
cells, which determine cell types on the basis of their size and volume. Because
some of cavaliers' platelets are so large, automated blood cell counters may not
recognize platelets as being platelets (treating them as if they were the larger
red blood cells) and undercount them, thereby inaccurately
lowering the platelet count. In a 2004 Danish study and the
2007 Italian study,
the researchers found that all of their CKCS platelet counts using three
different automated systems underestimated the actual counts determined
manually. Antech Diagnostics, the largest veterinary diagnostic laboratory,
specifically states on its website that "Platelets in this breed should be
counted manually, because automated blood cell counters cannot distinguish the
large platelets from erythrocytes [red blood cells] and therefore underestimate the true platelet
count." In some cases, false counts of platelets by automated blood
analyzers has been referred to as "Pseudothrombocytopenia"
(PTCP).
An accurate platelet count usually can be obtained by visually counting the cells. However, when counting the platelets manually, technician must be aware of the likelihood of the presence of oversized platelets, so that they are included in the count and not confused with other cells.
Not all manual counts of platelets are accurate, however. In a June 2018 article, a team of Italian three veterinarians examined blood smears from 30 dogs to count platelet numbers and determine the mean platelet count for each dog. They report finding that variabilities of platelet count estimates are high, operator-dependent, and influenced by the area of the blood smear. They found that platelet estimates by different observers could lead to a different classifications (thrombocytopenic or not) of the same dog. They concluded that platelet estimates alone are not precise enough to allow a reliable evaluation of platelet mass, and that their findings should encourage the establishment of standard guidelines tto perform reliable platelet estimates.
Also, because the large platelets are so fragile, any blood samples should be extracted very carefully. Therefore, all blood samples from cavaliers should be taken in a very careful manner and preferably only from the dog's jugular vein, using a large bore needle, and then should be examined only under a microscope by an experienced clinical pathologist before making a diagnosis of low platelet count. The 2004 US study report recommends that the blood be anticoagulated with ethylenediamine-tetraacetic acid (EDTA) and citrate.
RETURN TO TOP
• plateletcrit method
The days of mis-diagnosis of thrombocytopenia in cavaliers may be over! IDEXX Laboratories has developed a hematology analyzer using fluorescent optics which measures the volume of platelets (called plateletcrit) in a blood sample.
This procedure has been found in a 2008 Swedish study to be superior to the customary manual and automated platelet counts for assessing the platelet status of cavaliers. The device is called the IDEXX VetAutoread Hematology Analyzer. In their report, the researchers, Harold Tvedten, Inger Lilliehöök, Anna Hillström, and Jens Häggström, reported:
"The major purpose of this study was to compare the QBC [IDEXX VetAutoread Hematology Analyzer] platelet results with platelet counts from other automated and manual methods for evaluating platelet status in CKCS dogs. ... Platelet counts were determined in fresh EDTA blood from 27 adult CKCS dogs using the QBC, Sysmex XT-2000iV (optical and impedance), CELL-DYN 3500, blood smear estimate, and manual methods. Sysmex optical platelet counts were reanalyzed following gating to determine the number and percentage of normal- and large-sized platelets in each blood sample.
"Results: None of the 27 CKCS dogs had thrombocytopenia (defined as <164 × 109 platelets/L) based on the QBC platelet count. Fourteen (52%) to 18 (66%) of the dogs had thrombocytopenia with other methods. The percentage of large platelets, as determined by regating the Sysmex optical platelet counts, ranged from 1% to 75%, in a gradual continuum. Conclusions: The QBC may be the best analyzer for assessing clinically relevant thrombocytopenia in CKCS dogs, because its platelet count is based on the plateletcrit, a measurement of platelet mass."
In view of the 2008 Swedish study's finding of no thrombocytopenia in any of the 27 cavaliers, it could be that the breed does not suffer from thrombocytopenia, but instead has been the victim of platelet counting methods which rely upon the number of platelets rather than their overall volume. Macrothrombocytosis -- oversized platelets -- still were found in this study. Researchers in the 2008 study found that the platelet volume is more important than the numbers for the function of the platelets.
In a 2012 study, the same team of Swedish researchers compared the results from IDEXX's VetAutoread hematology analyzer with a Bayer Diagnositics' device, the Advia 2120 plateletcrit analyzer, for 43 cavaliers and 15 other dogs. The results showed that Advia's platelcrit readings were lower than those found by the IDEXX device for cavaliers which had the lowest plateletcrits.
Similarly, in a January 2013 master's thesis, University of Minnesota student Jessica Anne Kelley studied blood tests of 139 CKCSs, to investigate the use of the plateletcrit as an assessment of total platelet biomass in cavaliers with macrothrombocytopenia. She concluded:
"In this particular model of an inherited asymptomatic macrothrombocytopenic platelet disorder, Cavalier King Charles Spaniels represent a group of individuals in which the bleeding risk is better evaluated using plateletcrit than platelet number. The platelet mass appears significantly lower in affected dogs when measured by count, but when measured by plateletcrit, more of the patients are appropriately within the reference range. Therefore, for the Cavalier King Charles Spaniels affected by this mutation, plateletcrit better represents the true total platelet biomass in peripheral circulation."
RETURN TO TOP
DNA Testing
 Veterinary researchers at Auburn University have devised a DNA test for CKCSs
suspected of having oversized platelets. In
their 2008 report, the research team identified a mutation in the gene that
encodes beta1-tubulin (β1-tubulin gene), a protein involved in platelet production by
megakaryocytes. Their DNA test is available to determine the presence or absence
of this mutation. For more information about this DNA test, contact Dr.
Peter Christopherson at Auburn Univ., telephone 334-844-2697, email
chrispw@auburn.edu, or
click here for the webpage.
Veterinary researchers at Auburn University have devised a DNA test for CKCSs
suspected of having oversized platelets. In
their 2008 report, the research team identified a mutation in the gene that
encodes beta1-tubulin (β1-tubulin gene), a protein involved in platelet production by
megakaryocytes. Their DNA test is available to determine the presence or absence
of this mutation. For more information about this DNA test, contact Dr.
Peter Christopherson at Auburn Univ., telephone 334-844-2697, email
chrispw@auburn.edu, or
click here for the webpage.
RETURN TO TOP
Treatment
Absolutely no treatment is recommended unless the dog shows other symptoms of a blood-related disorder.
Cavaliers should not be treated for immune-mediated thrombocytopenia (IMT) as a precaution. Dog really suffering from IMT must be treated quickly, usually with intravenous doses of immunosuppressive drugs -- steroids, azathioprine, cyclosporine A and others -- to save the dog's life. Such treatments are severe and could do major damage to the healthy cavalier with nothing more than a low platelet count.
In a March 2024 article, Taiwan veterinarians report a case study of a young male cavalier with low blood platelet counts and with observed very large platelets and no symptoms of thrombocytopenia, which the general practice clinicians nevertheless treated with high oral doses of prednisolone and other drugs, without any improvement in the platelet counts. They report that the clinicians' periodic physical examinations of the dog "revealed no abnormalities ... No abnormalities were detected by abdominal radiography or ultrasonography." Prior to medication, the "number of red blood cells and white blood cell counts were all within normal limits. No signs of immune-mediated diseases were observed."
Due to the medications, particularly the high doses of immune-suppresing prednisolone, the dog's condition worsened. He developed anemia, and his white blood cell count shot up (leukocytosis), as did his ALP and ALT levels, suggesting the onset of kidney failure. The treating veterinarians finally discontinued the steroids and referred the cavalier to specialists, Tzu-Yi Ma, Chih-Jung Kuo, Chih-Chung Chou, and Pin-Chen Liu (right, above), who also have authored this report. They diagnosed the benign condition of asymptomatic inherited macrothrombocytopenia, acknowledging that "Inherited macrothrombocytopenia of CKCS has not been documented in Taiwan till date." The specialists attributed the leukocytosis and anemia to a "systemic infection related to steroid treatment."
RETURN TO TOP
Research Studies' Findings
• platelet size and counting issues
 A
2002 Danish study report (Drs. Henrik D. Pedersen, Jens Häggström, Lisbeth H.
Olsen, and others) concluded that cavaliers' oversized platelets could lead to
erroneous diagnoses of thrombocytopenia when automated blood counters are used.
An erroneous diagnosis of low platelet counts could result in unnecessary
diagnostic tests for the cavaliers.
A
2002 Danish study report (Drs. Henrik D. Pedersen, Jens Häggström, Lisbeth H.
Olsen, and others) concluded that cavaliers' oversized platelets could lead to
erroneous diagnoses of thrombocytopenia when automated blood counters are used.
An erroneous diagnosis of low platelet counts could result in unnecessary
diagnostic tests for the cavaliers.
A 2005 Australian study (Drs. M. K. Singh and W. A. Lamb) of 152 cavalier King Charles spaniels, all from New South Wales, found that the platelet count of the cavaliers, as a group, was only 32% that of the mixed breed control dogs, and that 30% of the CKCS in the study had macrothrombocytes. The Australian researchers concluded that the data supported an autosomal recessive inheritance pattern.
In a 2007 Italian study (Drs. W. Bertazzolo, S. Comazzi, L. Sesso, P. Scarpa, G. Ru, and S. Paltrinieri), the researchers compared platelet counts, platelet estimations and platelet parameters in 41 cavaliers measured by different methods -- impedance cell counter, laser cell counter and microscopic estimation -- commonly used in veterinary hospitals and commercial laboratories. Quantitative buffy coat analysis was performed on 17 of the samples, selected from cavaliers which had low platelet counts detected by the cell counters. CKCSs with macrothrombocytes had significantly lower counts on impedance cell counter (34.1% dogs below normal -- < 1003×109/l), laser cell counter (26.8%) and microscopic estimation (22.0%). The quantitative buffy coat analyser result was only 5.8% below normal.
In a 2008 study at Auburn University (Drs. B. Davis, M. Toivio-Kinnucan, S. Schuller, M.K. Boudreaux) determined that "a mutation in the gene encoding β1-tubulin [TUBB1 gene] correlated with macrothrombocytopenia in CKCS." They concluded that "this information will aid in distinguishing inherited from acquired thrombocytopenia. It also provides insight into the mechanism of platelet production by megakaryocytes, and also may prove useful in understanding heart-related changes in macrothrombocytopenic CKCS with concurrent mitral valve regurgitation."
The Auburn researchers since have devised a DNA test for macrothrombocytopenia. See details at Diagnosis below.
In a June 2018 article, a team of Italian three veterinarians examined blood smears from 30 dogs to count platelet numbers and determine the mean platelet count for each dog. They report finding that variabilities of platelet count estimates are high, operator-dependent, and influenced by the area of the blood smear. They found that platelet estimates by different observers could lead to a different classifications (thrombocytopenic or not) of the same dog. They concluded that platelet estimates alone are not precise enough to allow a reliable evaluation of platelet mass, and that their findings should encourage the establishment of standard guidelines tto perform reliable platelet estimates.
RETURN TO TOP
• possible relationship with other disorders
• mitral valve disease
It has been shown in studies of humans that mitral valve regurgitation can cause a reduction in the quantity of platelets, as well as increase their size, and alter their aggregation. Also, an association between inherited giant platelet disease and early onset mitral valve disease (MVD) has been reported in a family of humans. See this January 1998 article.
In a 2003 Danish study (Drs. I. Tarnow, A. T. Kristensen, H. Texel, L. H. Olsen, and H. D. Pedersen), the researchers found that CKCSs with mild, moderate, and severe mitral valve regurgitation have decreased platelet function. So, mitral valve disease may be the underlying cause of both thrombocytopenia and macrothrombocytopenia in the cavalier King Charles spaniel. However, in a 2002 US study of 42 CKCSs, the researchers reported that: "There was no association of thrombocytopenia with murmurs, and no association of abnormal platelet aggregation with murmurs or thrombocytopenia."
In the 2004 US study led by Drs. Sara M. Cowan and Rebecca Gompf of the University of Tennessee, thrombocytopenia was present in 51.43% of the 69 CKCSs in the study, and macrothrombocytes were present in one third of the cavaliers. Co-incidentally, 38% of the dogs in the US study had cardiac murmurs. The American researchers found platelet ultrastructure to be normal. They have identified the disorder as Benign Inherited Giant Platelet Disorder (IGPD). They wrote that "further studies are indicated to determine ... any association with mitral endocardiosis [MVD]."
In a January 2010 report, Dr. Mark A. Oyama of the University of Pennsylvania suggested a linkage between oversized platelets in cavaliers and their significantly higher serotonin concentrations than in other breeds of dogs. Serotonin and transforming growth factor-β are believed to play major roles in transforming valvular interstitial cells (VIC) into a more active myofibroblast, which is an important component of MVD in cavaliers. Read here about Dr. Oyama's continued research of the link between CKCSs' giant platelets and MVD.
 In an
April 2014 report, members of the Danish team, Drs. S.E. Cremer,
A.T. Kristensen, M.J. Reimann, N.B. Eriksen, S.F. Petersen, C.B.
Marschner, I. Tarnow, and L.H. Olsen joined with USA's Dr. Mark Oyama to
report finding a link between high-level serotonin-binding and
highly-activated blood platelets and mitral valve disease and oversized
platelets in cavaliers. They studied the levels of serotonin-binding and
of platlet activation in 61 CKCSs and found that cavaliers with
moderate-severe MVD and severe MVD tended to have higher levels of
platelet activation, and that highly-active platelets and high-level
serotonin-binding was strongly associated with oversized platelets. They
concluded that further investigation into the significance of
serotonin-binding.
In an
April 2014 report, members of the Danish team, Drs. S.E. Cremer,
A.T. Kristensen, M.J. Reimann, N.B. Eriksen, S.F. Petersen, C.B.
Marschner, I. Tarnow, and L.H. Olsen joined with USA's Dr. Mark Oyama to
report finding a link between high-level serotonin-binding and
highly-activated blood platelets and mitral valve disease and oversized
platelets in cavaliers. They studied the levels of serotonin-binding and
of platlet activation in 61 CKCSs and found that cavaliers with
moderate-severe MVD and severe MVD tended to have higher levels of
platelet activation, and that highly-active platelets and high-level
serotonin-binding was strongly associated with oversized platelets. They
concluded that further investigation into the significance of
serotonin-binding.
In a July 2014 report, the international team found that platelet serotonin was elevated in cavaliers compared to other breeds, and that left ventricular myocardial and mitral valve leaflet tissue in deceased MVD dogs was elevated compared to dogs which died without cardiac disease.
However, in a
June
2015 study, the Danish team and Dr. Oyama analyzed blood samples of 62 cavalier King Charles
spaniels (15 healthy dogs; 18 with mild MVD; 19 with moderate-to-severe
MVD; and 10 in congestive heart failure). They were looking for (a) any
relationship between serotonin concentrations in blood platelets
("percentage of serotonin-positive platelets, level of surface-bound
platelet serotonin expression"), and (b) platelet activation, in CKCSs
with MVD. They found no differences in either surface-bound serotonin
expression or platelet activation among the four categories of cavaliers
in the study.
They did observe that dogs with low platelet
numbers (thrombocytopenic dogs) had significantly lower serum serotonin
concentrations than non-thrombocytopenic dogs. And, they found in 26 of
the dogs a "flow cytometry scatterplot subpopulation (FSSP)" of
platelets. Dogs with an FSSP had a higher percentage of
serotonin-positive platelets, and a higher level of surface-bound
serotonin expression, and higher platelet activation, than did dogs
without an FSSP. An FSSP was present in 93.8% of the thrombocytopenic
dogs and in 29.5% of the nonthrombocytopenic dogs. They concluded from
those observations that an FSSP of highly activated platelets with
pronounced serotonin binding was strongly associated with
thrombocytopenia but not with MVD.
In an April 2016 abstract, a team of Sweden researchers evaluated 50 cavaliers to determine if oversized platelets affected hemostasis (the stopping of a flow of blood) in CKCSs with mitral valve disease (MVD). They determined that left ventricular fractional shortening of the heart -- a marker of progressing MVD -- combined with macrothrombocytosis, and age were shown to be associated with a more activated hemostasis "might" have an implication in MVD progression in CKCS.
In an August 2016 article, Australian researchers examined 89 cavaliers to determine if measurements of blood platelet function relate to the severity of MVD in CKCSs which are not yet in heart failure. They measured (1) "mean platelet component" (MPC) concentration; (2) "platelet component distribution width" (PCDW); and (3) "closure times" (CT). MPC and PCDW are means of measuring platelet activation. CT is a measure of the time it takes for platelets to stick together and form a "plug", which is the beginning of forming a clot. Another objective was to investigate possible associations of these variables with markers of MVD severity (murmur grade, mitral valve backflow "jet size", and left atrial and left ventricular dimensions).
They found that MVD backflow jet size had a significant affect upon CT, which is a sign of platelet dysfunction. However, they also found that platelet activation, based upon MPC concentration and PCDW, "was not a feature of subclinical chronic valvular heart disease in CKCSs."
RETURN TO TOP
• episodic falling and fly catcher's syndromes
Some researchers have suggested that Epsiodic Falling Syndrome and Fly Catcher's Syndrome in cavaliers may be associated with the breed's form of thrombocytopenia. Drs. Jens Häggström and Clarence Kvart of Sweden have noted in a 1997 article that thromboembolic events in the cerebral circulation of blood may be involved in these syndromes.
RETURN TO TOP
• the serotonin connection
 Dr. Penny Watson
(right) of the University of Cambridge, who has been studying
pancreatitis in cavaliers for many years, opined at
a presentation in November 2014 the hypothesis that there may be a
relationship between the serotonin carried by blood platelets through the
vascular system to various organs, particularly the pancreas, the kidneys,
the liver, the central nervous system, and the mitral valves of the heart, all causing scarring of
and other damage to the tissues of these organs. She stated:
Dr. Penny Watson
(right) of the University of Cambridge, who has been studying
pancreatitis in cavaliers for many years, opined at
a presentation in November 2014 the hypothesis that there may be a
relationship between the serotonin carried by blood platelets through the
vascular system to various organs, particularly the pancreas, the kidneys,
the liver, the central nervous system, and the mitral valves of the heart, all causing scarring of
and other damage to the tissues of these organs. She stated:
"We had a theory that these dogs have an increased propensity to produce scar tissue, and that in fact they are doing it in multiple organs. So, there is so link between some of these diseases. ... When we look at the central nervous system in dogs with syringomyelia histologically, we find more fibrosis around blood vessels than you would normally find in a normal dog. ... We don't know what's causing the scarring in the pancreas. There is something causing it, and it seems to be coming up the ducts because that's where a lot of this is happening. And actually my theory at the moment is that it has something to do with the duct bacteria. And that theory has developed after seeing not one or two, but actually four or five cavaliers with chronic pancreatitis who respond very well to antibiotic therapy, metronidazole therapy specifically. And that's the sort of antibiotic that we use for overgrowth of bacteria in the small intestine, not the sort of antibiotic we use for other infections. And so I either think they've got gut bacteria coming up the duct, and perhaps their normal gut bacteria and it just that cavaliers' over-responding. Or, maybe there's something about their duct flora that's driving it, but I think there is a link there, somehow or another between the cavalier's gut flora and what's happening in the pancreas.
"Now why might they [cavaliers] be forming too much scar tissue? ... A current theory revolves around their platelets. Platelets are blood clotting cells. ... In cavaliers, about 50% of cavaliers in the UK have these macro-platelets, these jumbo platelets. ... Something in these cavaliers is stimulating these stellate cells to transform and produce lots of fibrous tissue. ... We noticed in cavaliers ... that there was a pattern of increased fibrosis in multiple organs, the kidneys particularly. Mitral valve disease isn't scarring. Mitral valve disease is myxomatous change. ... But the cells that produce that are valvular interstitial cells, and they are identical to the stellate cells in the pancreas. The current theory ... is that these little dogs might have something in their platelets that they are releasing when they are going through blood vessels into different organs that's tending to cause fibrosis. And our theory ... is that this might be serotonin, which is also known as 5-hydroxytryptamine, because platelets contain a bucket load of serotonin. ...
"We already know that some cavaliers have elevated levels of serotonin, that's been shown. We also already know that serotonin is central to converting those valvular interstitial cells into myofibroblasts. ... I think what was most compelling for me was the human side of it. There is a particular horrible syndrome in people called carcinoid syndrome. People who've got serotonin secreting tumors that they've got. ... They get pancreatic, liver, and kidney fibrosis and mitral valve disease. ... So in a nutshell, the hypothesis was these big floppy platelets release serotonin easily as they pass through vessels, leading to fibrosis in perivascular areas."
However, in a
June
2015 study, a Danish team and Dr. Oyama analyzed blood samples of 62 cavalier King Charles
spaniels (15 healthy dogs; 18 with mild MVD; 19 with moderate-to-severe
MVD; and 10 in congestive heart failure). They were looking for (a) any
relationship between serotonin concentrations in blood platelets
("percentage of serotonin-positive platelets, level of surface-bound
platelet serotonin expression"), and (b) platelet activation, in CKCSs
with MVD. They found no differences in either surface-bound serotonin
expression or platelet activation among the four categories of cavaliers
in the study.
They did observe that dogs with low platelet
numbers (thrombocytopenic dogs) had significantly lower serum serotonin
concentrations than non-thrombocytopenic dogs. And, they found in 26 of
the dogs a "flow cytometry scatterplot subpopulation (FSSP)" of
platelets. Dogs with an FSSP had a higher percentage of
serotonin-positive platelets, and a higher level of surface-bound
serotonin expression, and higher platelet activation, than did dogs
without an FSSP. An FSSP was present in 93.8% of the thrombocytopenic
dogs and in 29.5% of the nonthrombocytopenic dogs. They concluded from
those observations that an FSSP of highly activated platelets with
pronounced serotonin binding was strongly associated with
thrombocytopenia but not with MVD.
In a June 2019 article, Danish and Swedish cardiology researchers examined urinary excretions of serotonin (5-hydroxyindoleacetic acid [5-HIAA]) in 40 cavalier King Charles spaniels, 11 without mitral valve disease (MVD) and 29 with MVD prior to heart failure (Stage C) to determine if urine concentrations of 5-HIAA were associated with MVD severity or blood platelet count or circulating serotonin. They concluded that while female cavaliers had higher urine 5-HIAA concentrations than males, 5-HIAA concentrations in CKCSs were not associated with MVD severity or blood platelet count or circulating serotonin.
RETURN TO TOP
What You Can Do
It is essential that cavalier owners be aware of this benign platelet issue. Dogs undergo blood tests periodically for a variety of reasons, and platelet counts are standard elements of these tests. Veterinarians who are unaware that low platelet counts in CKCSs almost always are due to the fewer platelets being larger rather than to any serious blood deficiency (and, unfortunately, there are many such vets), may assume a life-threatening immune response disorder and perform completely unnecessary (and life-threatening) treatments, such as intravenous doses of steroids. Some vets have been known to start such treatments even before informing the dogs's owners. So, it is wise to inform the veterinarian, before any blood tests are performed, about this benign disorder.
RETURN TO TOP
Research News
May 2024:
ACVIM Consensus Statement on immune thrombocytopenia barely
mentions cavaliers' benign version.
 In a
May 2024 article,
the American College of Veterinary Internal Medicine (ACVIM) issued a
Consensus Statement by a panel of 26 specialists (Dana N. LeVine, Linda
Kidd [right], Oliver A. Garden, Marjory B. Brooks, Robert Goggs, Barbara Kohn,
Andrew J. Mackin, Erin R. B. Eldermire, Yu-Mei Chang, Julie Allen, Peter
W. Christopherson, Barbara Glanemann, Haruhiko Maruyama, Maria C.
Naskou, Lise N. Nielsen, Sarah Shropshire, Austin K. Viall, Adam J.
Birkenheuer, Marnin A. Forman, Andrew S. Hanzlicek, Kathrin F. Langner,
Erin Lashnits, Katharine F. Lunn, Kelly M. Makielski, Xavier Roura, Eva
Spada) on the topic of the diagnosis of immune thrombocytopenia (ITP) in
dogs and cats. They point out that "ITP is the most common acquired
primary hemostatic disorder in dogs." In their 24-page article, they
barely refer to the benign version of thrombocytopenia diagnosed
frequently in cavalier King Charles spaniels. They state:
In a
May 2024 article,
the American College of Veterinary Internal Medicine (ACVIM) issued a
Consensus Statement by a panel of 26 specialists (Dana N. LeVine, Linda
Kidd [right], Oliver A. Garden, Marjory B. Brooks, Robert Goggs, Barbara Kohn,
Andrew J. Mackin, Erin R. B. Eldermire, Yu-Mei Chang, Julie Allen, Peter
W. Christopherson, Barbara Glanemann, Haruhiko Maruyama, Maria C.
Naskou, Lise N. Nielsen, Sarah Shropshire, Austin K. Viall, Adam J.
Birkenheuer, Marnin A. Forman, Andrew S. Hanzlicek, Kathrin F. Langner,
Erin Lashnits, Katharine F. Lunn, Kelly M. Makielski, Xavier Roura, Eva
Spada) on the topic of the diagnosis of immune thrombocytopenia (ITP) in
dogs and cats. They point out that "ITP is the most common acquired
primary hemostatic disorder in dogs." In their 24-page article, they
barely refer to the benign version of thrombocytopenia diagnosed
frequently in cavalier King Charles spaniels. They state:
"Although not included in our systematic review, we recommend that identification of macrothrombocytes, particularly in healthy dogs lacking signs of a primary hemostatic defect and breeds, or mixed breeds, with hereditary macrothrombocytopenia, should prompt genetic testing early in the diagnostic evaluation."
They also offer a rather complicated algorithm (excerpted below), which, if followed, does offer hope that general practice veterinarians will avoid administering massive doses of potent immuno-suppressant steroid treatments to healthy members of our breed.

May 2024:
Taiwan clinicians realize almost too late that a cavalier with
low blood platelet counts does not need steroids.
 In a
March 2024 article,
Taiwan veterinarians report a case study of a young male cavalier King
Charles spaniel with
low blood platelet counts and with observed very large platelets and
no
symptoms of thrombocytopenia, which the general practice clinicians nevertheless treated with high oral doses of
prednisolone and other drugs, without any resulting improvement in the platelet
counts. They report that the clinicians' periodic physical examinations of the dog
"revealed no abnormalities ... No abnormalities were detected by
abdominal radiography or ultrasonography." Prior to medication, the
"number of red blood cells and white blood cell counts were all within
normal limits. No signs of immune-mediated diseases were observed."
In a
March 2024 article,
Taiwan veterinarians report a case study of a young male cavalier King
Charles spaniel with
low blood platelet counts and with observed very large platelets and
no
symptoms of thrombocytopenia, which the general practice clinicians nevertheless treated with high oral doses of
prednisolone and other drugs, without any resulting improvement in the platelet
counts. They report that the clinicians' periodic physical examinations of the dog
"revealed no abnormalities ... No abnormalities were detected by
abdominal radiography or ultrasonography." Prior to medication, the
"number of red blood cells and white blood cell counts were all within
normal limits. No signs of immune-mediated diseases were observed."
Due to the medications, particularly the high doses of immune-suppressing prednisolone, the dog's condition worsened. He developed anemia, and his white blood cell count shot up (leukocytosis), as did his ALP and ALT levels, suggesting the onset of kidney failure. The treating veterinarians finally discontinued the steroids and referred the cavalier to specialists, Tzu-Yi Ma, Chih-Jung Kuo, Chih-Chung Chou, and Pin-Chen Liu (right, above), who also have authored this report. They diagnosed the benign condition of asymptomatic inherited macrothrombocytopenia, acknowledging that "Inherited macrothrombocytopenia of CKCS has not been documented in Taiwan till date." The specialists attributed the leukocytosis and anemia to a "systemic infection related to steroid treatment."
EDITOR'S NOTE: This report is a poster child for how to nearly kill a perfectly healthy cavalier because of inexcusable ignorance on the part of the "treating" veterinarians. Had they administered the steroids by injection rather than orally, he surely would have been dead before the specialty vets had a go at him. If ever a case for Dr. Google existed, this is it. Google would have told them everything they needed to know about cavaliers with low platelet counts, in less than 0.34 seconds. (See image below.) Take the advice given by veterinary neurologist Dr. Clare Rusbridge:
"It is always worth doing a Google search for different breeds that you are not so familiar with just to see if there is any inherited diseases coming up."This cavalier had no signs of any bleeding disorder. "No abnormalities were detected. ... [the] number of red blood cells and white blood cell counts were all within normal limits. No signs of immune-mediated diseases were observed." They ignored all of that data and pumped him with high doses of steroids, plus doxycycline and famotidine, for at least 3 weeks!

June 2019:
Danish and Swedish researchers find no connection between
urinary serotonin concentration and blood platelet counts in cavaliers.
 In
a
June 2019 article, Danish and Swedish cardiology researchers
(L.B.Christiansen, S.E.Cremer, A. Helander, Tine Madsen, M.J. Reimann,
J.E. Møller, K. Höglund, I. Ljungvall, J. Häggström, L. Høier Olsen
[right]) examined urinary excretions of serotonin
(5-hydroxyindoleacetic acid [5-HIAA]) in 40 cavalier King Charles
spaniels, 11 without mitral valve disease (MVD) and 29 with MVD prior to
heart failure (Stage C) to determine if urine concentrations of 5-HIAA
were associated with MVD severity or blood platelet count or circulating
serotonin. They concluded that while female cavaliers had higher urine
5-HIAA concentrations than males, 5-HIAA concentrations in CKCSs were
not associated with MVD severity or blood platelet count or circulating
serotonin.
In
a
June 2019 article, Danish and Swedish cardiology researchers
(L.B.Christiansen, S.E.Cremer, A. Helander, Tine Madsen, M.J. Reimann,
J.E. Møller, K. Höglund, I. Ljungvall, J. Häggström, L. Høier Olsen
[right]) examined urinary excretions of serotonin
(5-hydroxyindoleacetic acid [5-HIAA]) in 40 cavalier King Charles
spaniels, 11 without mitral valve disease (MVD) and 29 with MVD prior to
heart failure (Stage C) to determine if urine concentrations of 5-HIAA
were associated with MVD severity or blood platelet count or circulating
serotonin. They concluded that while female cavaliers had higher urine
5-HIAA concentrations than males, 5-HIAA concentrations in CKCSs were
not associated with MVD severity or blood platelet count or circulating
serotonin.
September 2018:
UK cardiologists find no association between macroplatelets and
pulmonary hypertension. In an
April 2018 abstract, UK cardiologists Siddharth Sudunagunta and Jo
Dukes-McEwan (left) report their
 study
of 94 MVD-affected cavalier King Charles spaniels and 93 MVD-affected
non-CKCSs to determine if cavaliers are more likely to develop pulmonary
hypertension (PH) due to mitral valve disease, and also determine
whether there is any association between CKCSs' oversized blood
platelets (macroplatelets) and PH. All dogs had enlarged hearts due to
their MVD. 57 of the 94 cavaliers were in congestive heart failure (CHF)
compared to 45 of the non-CKCSs. 71 of the cavaliers had PH, compared to
52 of the non-CKCSs. They found:
study
of 94 MVD-affected cavalier King Charles spaniels and 93 MVD-affected
non-CKCSs to determine if cavaliers are more likely to develop pulmonary
hypertension (PH) due to mitral valve disease, and also determine
whether there is any association between CKCSs' oversized blood
platelets (macroplatelets) and PH. All dogs had enlarged hearts due to
their MVD. 57 of the 94 cavaliers were in congestive heart failure (CHF)
compared to 45 of the non-CKCSs. 71 of the cavaliers had PH, compared to
52 of the non-CKCSs. They found:
• PH was associated with a greater likelihood of CHF and death (cardiac-related and all-cause mortality).
• CKCSs were more likely to experience cardiac death than non-CKCSs.
• Macroplatelets were not associated with PH development.
• CKCS were more likely than non-CKCS to develop PH due to MVD.
June 2018:
Italian researchers find that platelet estimates from blood
smears are too imprecise to be reliable.
 In a
June 2018 article, a team of Italian three veterinarians, led by a
board certified pathologist (Saverio Paltrinieri [right],
Veronica Paciletti, Jari Zambarbieri), examined blood smears from 30
dogs to count platelet numbers and determine the mean platelet count for
each dog. They report finding that variabilities of platelet count
estimates are high, operator-dependent, and influenced by the area of
the blood smear. They found that platelet estimates by different
observers could lead to a different classifications (thrombocytopenic or
not) of the same dog. They concluded that platelet estimates alone are
not precise enough to allow a reliable evaluation of platelet mass, and
that their findings should encourage the establishment of standard
guidelines tto perform reliable platelet estimates.
In a
June 2018 article, a team of Italian three veterinarians, led by a
board certified pathologist (Saverio Paltrinieri [right],
Veronica Paciletti, Jari Zambarbieri), examined blood smears from 30
dogs to count platelet numbers and determine the mean platelet count for
each dog. They report finding that variabilities of platelet count
estimates are high, operator-dependent, and influenced by the area of
the blood smear. They found that platelet estimates by different
observers could lead to a different classifications (thrombocytopenic or
not) of the same dog. They concluded that platelet estimates alone are
not precise enough to allow a reliable evaluation of platelet mass, and
that their findings should encourage the establishment of standard
guidelines tto perform reliable platelet estimates.
May 2018:
Australian researcher reports on the affect of MVD
severity upon platelet function and activation in CKCSs.
 In a
2017
master's thesis, Australian veterinary internal medicine specialist
Linda Tong (right) reports on her study of blood platelets in 89
cavalier King Charles spaniels and a 39-dog control group, to
investigate associations between markers of Stage B1 and B2 mitral valve
disease (MVD) and platelet function or activation. As a part of her
study, she examined the 89 CKCSs to determine the frequency of MVD in
the dogs. She found at least minimal mitral regurgitation via
echocardiography in 86 of the 89 dogs (97%), and an MVD murmur using
auscultation in 47% of the cavaliers at age 6 years or less. She
concluded:
In a
2017
master's thesis, Australian veterinary internal medicine specialist
Linda Tong (right) reports on her study of blood platelets in 89
cavalier King Charles spaniels and a 39-dog control group, to
investigate associations between markers of Stage B1 and B2 mitral valve
disease (MVD) and platelet function or activation. As a part of her
study, she examined the 89 CKCSs to determine the frequency of MVD in
the dogs. She found at least minimal mitral regurgitation via
echocardiography in 86 of the 89 dogs (97%), and an MVD murmur using
auscultation in 47% of the cavaliers at age 6 years or less. She
concluded:
"In the present study, a significant effect of mitral valve regurgitant jet size on closure time was consistent with platelet dysfunction. However, platelet activation, as determined by MPC [mean platelet component] concentration and PCDW [platelet component distribution width], was not a feature of subclinical CVHD [MVD] in CKCS."
(See aslo this July 2016 item below.)
November 2016: Belgian researchers recommend all cavaliers be tested for oversized platelets and mated accordingly. In an October 2016 report, a team of Belgian researchers (E. Beckers, M. Van Poucke, L. Ronsyn, Luc Peelman) found 46.6% of 57 Belgian cavalier King Charles spaniels had the macrothrombocytopenia (MTC) mutation. They acknowledged that:
"This disorder is not a disease per se, since affected animals do not usually have bleeding tendencies. The main problem is situated in unnecessary treatments with antibiotics or corticosteroids, which are often given because of the abnormal blood parameters."
Nevertheless, they raise the spectre that, "Animals with this mutation have a shortage of platelets and may potentially develop problems in the primary hemostasis [the stopping of a flow of blood]." They conclude:
"Macrothrombocytopenia should be tested in all Cavalier King Charles spaniels. Heterozygotes for these mutations and even homozygotes for the less severe disorders should not be routinely excluded from breeding programs, since this may lead to an even more important decrease in genetic diversity of breeds with an already (relatively) small genetic basis. Instead, the results of the genotyping should be used to make a well-reasoned partner choice."
 EDITOR'S
NOTE: The researchers make two recommendations here which
appear to be unfounded. They certainly do not offer any evidence to
support the recommendations. First, they suggest "Animals with this
mutation have a shortage of platelets and may potentially develop
problems in the primary hemostasis [the stopping of a flow of blood]."
It is not nice to unnecessarily scare cavalier owners, don't you know?
EDITOR'S
NOTE: The researchers make two recommendations here which
appear to be unfounded. They certainly do not offer any evidence to
support the recommendations. First, they suggest "Animals with this
mutation have a shortage of platelets and may potentially develop
problems in the primary hemostasis [the stopping of a flow of blood]."
It is not nice to unnecessarily scare cavalier owners, don't you know?
Second, they recommend that "Macrothrombocytopenia should be tested in all Cavalier King Charles spaniels." They apparently do so because they think that CKCS breeders should use the resulting information in their mating selections. That is rather absurd when you consider that probably more than half of all cavaliers have oversized platelets and that condition has not caused any health problems in the breed, at all. What we have here is a textbook example of "over-diagnosis" (a syndrome affecting more and more veterinarians everyday).
July 2016: Australian researchers measure blood platelet function in cavaliers with pre-heart failure MVD. In an August 2016 report, a team of Australian researchers (Linda J. Tong, Giselle L. Hosgood, Peter J. Irwin, Robert E. Shie) and a Scottish researcher (Anne T. French) examined 89 cavalier King Charles spaniels to determine if measurements of blood platelet function relate to the severity of MVD in CKCSs not yet in heart failure. They measured (1) "mean platelet component" (MPC) concentration; (2) "platelet component distribution width" (PCDW); and (3) "closure times" (CT). MPC and PCDW are means of measuring platelet activation. CT is a measure of the time it takes for platelets to stick together and form a "plug", which is the beginning of forming a clot. Another objective was to investigate possible associations of these variables with markers of MVD severity (murmur grade, mitral valve backflow "jet size", and left atrial and left ventricular dimensions).
They found that MVD backflow jet size had a significant affect upon CT, which is a sign of platelet dysfunction. However, they also found that platelet activation, based upon MPC concentration and PCDW, "was not a feature of subclinical chronic valvular heart disease in CKCSs." (See also this May 2018 item above.)
July 2015:
Univ. of
Minnesota pathologists report more breeds with the CKCS giant platelet
disorder. In a July 2015
article, University of Minnesota veterinary pathologists Drs. Leslie
Sharkey (right) and Daniel Heinrich report that the benign
giant platelet disorder so common in cavalier King Charles spaniels also
has been discovered in several other breeds. They state:
In a July 2015
article, University of Minnesota veterinary pathologists Drs. Leslie
Sharkey (right) and Daniel Heinrich report that the benign
giant platelet disorder so common in cavalier King Charles spaniels also
has been discovered in several other breeds. They state:
"Keep in mind that an expanding number of breeds have congenital macrothrombocytopenia initially characterized in Cavalier King Charles spaniels; these breeds include Norfolk and Cairn terriers, Chihuahuas, Labrador retrievers, poodles, English toy spaniels, shih tzus, Maltese, Jack Russell terriers, Havanese, boxers, cocker spaniels, bichons frises, and some mixed breeds."
They make the important note that a lack of history of unusual bleeding usually is a sign of this syndrome.
May 2015:
Researchers do not find a relationship between serotonin in blood
platelets and development of MVD in cavaliers. In a
June
2015 study, an international team of veterinary researchers (Signe E.
Cremer, Annemarie T. Kristensen, Maria J. Reimann, Nynne B. Eriksen,
Stine F. Petersen, Clara B. Marschner, Inge Tarnow, Mark A. Oyama,
Lisbeth H. Olsen) analyzed blood samples of 62 cavalier King Charles
spaniels (15 healthy dogs; 18 with mild MVD; 19 with moderate-to-severe
MVD; and 10 in congestive heart failure). They were looking for (a) any
relationship between serotonin concentrations in blood platelets
("percentage of serotonin-positive platelets, level of surface-bound
platelet serotonin expression"), and (b) platelet activation, in CKCSs
with MVD. They found no differences in either surface-bound serotonin
expression or platelet activation among the four categories of cavaliers
in the study.
They did observe that dogs with low platelet
numbers (thrombocytopenic dogs) had significantly lower serum serotonin
concentrations than non-thrombocytopenic dogs. And, they found in 26 of
the dogs a "flow cytometry scatterplot subpopulation (FSSP)" of
platelets. Dogs with an FSSP had a higher percentage of
serotonin-positive platelets, and a higher level of surface-bound
serotonin expression, and higher platelet activation, than did dogs
without an FSSP. An FSSP was present in 93.8% of the thrombocytopenic
dogs and in 29.5% of the nonthrombocytopenic dogs. They concluded from
those observations that an FSSP of highly activated platelets with
pronounced serotonin binding was strongly associated with
thrombocytopenia but not with MVD.
February 2015: Swedish study finds serotonin levels increase in spayed bitches. In a February 2015 report by veterinary doctoral student Elin Larsson, she studied 7 female dogs and 3 males, including on cavalier King Charles spaniel male, she found that "Among the bitches, the serotonin levels tended to increase after castration [sic]. The male dogs were few in number and no obvious changes in hormone levels were shown."
 January 2015:
Dr. Penny Watson discusses CKCS platelets and serotonin's
possible connection with MVD, SM, and pancreatitis. In "Pancreatitis
in Cavaliers: What is it and what can I do about it?" A DVD
(right)
of
a seminar presented by Dr. Penny Watson of the University of Cambridge,
UK in November 2014, is available for purchase from Cavalier
Matters.
January 2015:
Dr. Penny Watson discusses CKCS platelets and serotonin's
possible connection with MVD, SM, and pancreatitis. In "Pancreatitis
in Cavaliers: What is it and what can I do about it?" A DVD
(right)
of
a seminar presented by Dr. Penny Watson of the University of Cambridge,
UK in November 2014, is available for purchase from Cavalier
Matters.
In her presentation, Dr. Watson discussed a current hypothesis which links mitral valve disease and pancreatitis and kidney disease in cavaliers through the secretion of serotonin by the cavaliers' blood platelets. She stated:
"We noticed in cavaliers ... that there was a pattern of increased fibrosis in multiple organs, the kidneys particularly. Mitral valve disease isn't scarring. Mitral valve disease is myxomatous change. ... But the cells that produce that are valvular interstitial cells, and they are identical to the stellate cells in the pancreas. The current theory ... is that these little dogs might have something in their platelets that they are releasing when they are going through blood vessels into different organs that's tending to cause fibrosis. And our theory ... is that this might be serotonin, which is also known as 5-hydroxytryptamine, because platelets contain a bucket load of serotonin. ... We already know that some cavaliers have elevated levels of serotonin, that's been shown. We also already know that serotonin is central to converting those valvular interstitial cells into myofibroblasts. ... I think what was most compelling for me was the human side of it. There is a particular horrible syndrome in people called carcinoid syndrome. People who've got serotonin secreting tumors that they've got. ... They get pancreatic, liver, and kidney fibrosis and mitral valve disease. ... So in a nutshell, the hypothesis was these big floppy platelets release serotonin easily as they pass through vessels, leading to fibrosis in perivascular areas."
July 2014: International team of cardiologists find cavaliers have higher serotonin concentrations in platelets. In a July 2014 study, cardiologist researchers from Denmark, the USA, and France (S.E. Cremer, G.E. Singletary, L.H. Olsen, K. Wallace, J. Häggström, I. Ljungvall, K. Höglund, C.A. Reynolds, N. Pizzinat, M.A. Oyama) compared serotonin concentrations in blood plasma of 26 cavaliers (12 healthy and 14 with mitral valve disease) and 19 non-CKCSs (8 healthy and 11 with MVD). They found that platelet serotonin was elevated in cavaliers compared to the other breeds. They also found that left ventricular myocardial and mitral valve leaflet tissue in deceased MVD dogs was elevated compared to dogs which died without cardiac disease.
May 2014:
International team finds link between high-level serotonin-binding and
highly-activated blood platelets and mitral valve disease and oversized
platelets in cavaliers.
 In an
April 2014 report, a team of
researchers from Denmark and the USA studied the levels of
serotonin-binding and of platlet activation in 61 CKCSs. They found that
cavaliers with moderate-severe MVD and severe MVD tended to have higher
levels of platelet activation, and that highly-active platelets and
high-level serotonin-binding was strongly associated with oversized
platelets. They concluded that further investigation into the
significance of serotonin-binding is warranted.
In an
April 2014 report, a team of
researchers from Denmark and the USA studied the levels of
serotonin-binding and of platlet activation in 61 CKCSs. They found that
cavaliers with moderate-severe MVD and severe MVD tended to have higher
levels of platelet activation, and that highly-active platelets and
high-level serotonin-binding was strongly associated with oversized
platelets. They concluded that further investigation into the
significance of serotonin-binding is warranted.
January 2013: University of Minnesota student's master's thesis confirms superiority of Advia's plateletcrit method. In a January 2013 master's thesis, University of Minnesota student Jessica Anne Kelley studied blood tests of 139 cavalier King Charles spaniels, to investigate the use of the plateletcrit as an assessment of total platelet biomass in cavaliers with asymptomatic congenital macrothrombocytopenia. She concluded:
"In this particular model of an inherited asymptomatic macrothrombocytopenic platelet disorder, Cavalier King Charles Spaniels represent a group of individuals in which the bleeding risk is better evaluated using plateletcrit than platelet number. The platelet mass appears significantly lower in affected dogs when measured by count, but when measured by plateletcrit, more of the patients are appropriately within the reference range. Therefore, for the Cavalier King Charles Spaniels affected by this mutation, plateletcrit better represents the true total platelet biomass in peripheral circulation."
See also, the January 2014 published version of this article, below.
September
2012:
IDEXX's VetAutoread hematology analyzer tops Bayer Diagnostic's Advia![]() 2120 in
measurement of CKCS plateletcrits. Swedish researchers find that
Bayer Diagnositics' Advia 2120 plateletcrit analysis of cavaliers was lower than
expected, when compared to results from IDEXX's VetAutoread hematology analyzer.
Read more here.
2120 in
measurement of CKCS plateletcrits. Swedish researchers find that
Bayer Diagnositics' Advia 2120 plateletcrit analysis of cavaliers was lower than
expected, when compared to results from IDEXX's VetAutoread hematology analyzer.
Read more here.
September 2011: Auburn Univ. offers DNA test for inherited macrothrombocytopenia in cavaliers. Veterinary researchers at Auburn University have devised a DNA test for CKCSs suspected of having oversized platelets. In their 2008 report, the research team identified a mutation in the gene that encodes beta1-tubulin, a protein involved in platelet production by megakaryocytes. Their DNA test is available to determine the presence or absence of this mutation. For more information about this DNA test, contact Dr. Mary K. Boudreaux at Auburn Univ., telephone 334-844-2692, email boudrmk@auburn.edu, or click here for the webpage.
The researchers advise that inherited macrothrombocytopenia should be suspected in any dog that has a persistently low platelet counts and that is non-responsive to treatment with antibiotics or steroids and has no history or evidence of abnormal bleeding. Since the identification of this mutation in CKCS, the identical mutation has also been documented in other breeds of dogs with inherited macrothrombocytopenia including Chihuahua, Labrador retriever, Poodle, English toy spaniel, Labradoodle, Shih Tzu, Maltese, and Jack Russell.
Editor's Note: Oversized platelets in the cavalier King Charles spaniel should not come as a surprise, and in view of the widespread extent of severely symptomatic disorders in the CKCS, such as mitral valve disease and syringomyelia, it is unreasonable to exclude cavaliers with idiopathic asymptomatic thrombocytopenia from being bred. So, we see little value in testing cavalier breeding stock to detect macrothrombocytopenia.
July 2011: Geneticist Lowell Ackerman opposes breeding cavaliers with genetic platelet disorders. In his just-released second edition of his book, Genetic Connection: A Guide to Health Problems in Purebred Dogs, geneticist Dr. Lowell Ackerman states:
"An asymptomatic thrombocytipenia typically, but not always, associated with large to giant platelets has been reported in the Cavalier King Charles spaniel. The condition, macrothrombocytopenia, has been reported as an autosomal recessive trait in the breed, and the molecular basis for the condition is a mutation in the gene encoding β-1 tubulin. The diagnosis should be suspected when thrombocytopenia and large platelets are reported in this breed without evidence of bleeding diathesis. No treatment is necessary. Despite the fact that this disorder appears to be asymptomatic, it would seem prudent not to use affected animals for breeding. Genetic testing is now available for identifying affected, carrier, and clear individuals."
Editor's Note: In view of the widespread extent of severely symptomatic disorders in the CKCS, such as mitral valve disease and syringomyelia, it is unreasonable to exclude cavaliers with idiopathic asymptomatic thrombocytopenia from being bred.
December 2010: Dr. Oyama studies links between cavaliers' giant platelets and MVD. Dr. Mark A. Oyama of the University of Pennsylvania is continuing his research into links between cavaliers' giant platelets and the breed's high incidence of mitral valve disease. His previous research has shown that CKCSs have elevated levels of serotonin (5-HT). The hypothesis is that 5-HT signaling is an important component of MVD in dogs. He suspects that the source of elevated serum 5HT is the blood platelets, since platelets are believed to contain 99% of all circulating 5-HT. It has been recently shown that platelet contents can activate disease changes within the heart muscle of experimental animals. The platelet, heart muscle, and valve-specific content of 5-HT in dogs with heart disease has not been previously reported. Dr. Oyama wants to determine if platelet 5-HT is the source of elevated serum 5-HT in cavaliers with MVD, as well as to quantify the amount of 5-HT in both the left ventricular muscle and mitral valve leaflets of affected dogs.
May
2008: Auburn University team finds gene mutation related
to macrothrombocytopenia in CKCSs.
 In a 2008 study at Auburn University (Drs.
Jennifer Brooke Davis, M. Toivio-Kinnucan, S.
Schuller, Mary K. Boudreaux) determined that "a mutation in the gene encoding β1-tubulin
correlated with macrothrombocytopenia in CKCS." They concluded that "this
information will aid in distinguishing inherited from acquired thrombocytopenia.
It also provides insight into the mechanism of platelet production by megakaryocytes, and also may prove useful in understanding heart-related changes
in macrothrombocytopenic CKCS with concurrent mitral valve regurgitation."
In a 2008 study at Auburn University (Drs.
Jennifer Brooke Davis, M. Toivio-Kinnucan, S.
Schuller, Mary K. Boudreaux) determined that "a mutation in the gene encoding β1-tubulin
correlated with macrothrombocytopenia in CKCS." They concluded that "this
information will aid in distinguishing inherited from acquired thrombocytopenia.
It also provides insight into the mechanism of platelet production by megakaryocytes, and also may prove useful in understanding heart-related changes
in macrothrombocytopenic CKCS with concurrent mitral valve regurgitation."
2007: Auburn Univ. student Jennifer Brooke Davis finds genetic mutation in cavaliers' blood platelets. Morris Animal Foundation reports the results of a funded study by an Auburn University student, Jennifer Brooke Davis, who examined the molecular basis for inherited macrothrombocytopenia in CKCSs.
2007: Dr. Inge Tarnow, at the University of Copenhagen's Department of Animal and Veterinary Basic Sciences, heads a group of specialists studying pathophysiological aspects of early mitral valve diseases in cavaliers, including changes in platelet function, hemostatic changes, and prognostic factors. They currently are performing a large longitudinal study of 100 Cavaliers with examinations (echocardiographic and blood tests) at ages 2, 4, and 8 years.
RETURN TO TOP
Related Links
RETURN TO TOP
Veterinary Resources
Macrothrombocytosis in cavalier King Charles spaniels. Brown SJ, Simpson KW, Baker S, Spagnoletti MA, Elwood CM. Vet Rec. 1994 Sep 17;135(12):281-3. Quote: "Low platelet counts (< 150 x 10(9)/litre) have been measured by autoanalyser in cavalier King Charles spaniels with a wide range of diseases. However, the direct examination of blood smears revealed adequate numbers of platelets but many abnormally large platelets and it was not clear whether the large platelets were the result of disease or a breed abnormality. The numbers and diameters of the platelets in a group of clinically normal King Charles spaniels and a group of other breeds were measured by autoanalyser and manually. The automated platelet counts were lower in the King Charles spaniels than in the other breeds (P < 0.01), but the manual counts were similar. The platelet diameter was greater in the cavalier King Charles spaniels (median values 2.5 to 3.75 microns, P < 0.001) than the other breeds (median values 1.25 to 2.5 microns) and had a bimodal distribution with peaks at 1.25 to 2.5 microns and 3.75 to 5 microns. No clinical evidence of platelet dysfunction was detected. These findings indicate that cavalier King Charles spaniels may have large platelets which could lead to the erroneous diagnosis of thrombocytopenia by automated haematological analysis."
Thrombocytopenia in the Cavalier King Charles Spaniel. Eskell P, Häggström J, Kvart C, Karlsson A. J Small Anim Pract 1994; 35:153-155. Quote: "Blood samples were collected for the determination of platelet counts from 102 cavalier King Charles spaniels which had no history of bleeding disorders. Thrombocytopenia was found in 31 per cent of the samples when the lower reference limit was set at 100 X 109/litre. The platelet count of the males (mean ± SD, 147 X 109/litre ± 15 X 109/litre) was found to be significantly (P<0.05) lower than that of the females (mean ± SD, 202 X 109/litre ± 13 X 109/litre). The platelet counts from a reference group of 16 normal beagles, analysed identically, were not lower than 189 X 109/litre and no significant difference was found between males (mean ± SD, 249 X 109/litre ± 14 X 109/litre) and females (mean ± SD, 282 X 109/litre ± 20 X 109/litre)."
Idiopathic, asymptomatic thrombocytopenia in Cavalier King Charles spaniels: 11 cases (1983-1993). Smedile LE, Houston DM, Taylor SM, Post K, Searcy GP. J Am Anim Hosp Assoc. 1997 Sep-Oct;33(5):411-5.
Macrothrombocytosis in a Cavalier King Charles Spaniel. Kraus MS. Veterinary Forum, May, 1997.
Update on Mitral Valve Disease. Jens Häggström and Clarence Kvart. Proc. 15th ACVIM Forum; 1997. Quote: "An interesting observation that may be of comparative interest is that Cavalier King Charles Spaniels have been shown to have a high prevalence (30%) of thrombocytopenia and macrothrombocytosis. Humans with MVP [mitral valve prolapse] tend to have shortened platelet survival times and thromboembolic episodes primarily in the retinal and cerebral circulation. Thromboembolic events in the retinal ore cerebral circulation may be involved in the disturbances described in the breed as 'episodic falling' and 'fly catching'."
Giant platelets with abnormal surface glycoproteins: a new familial disorder associated with mitral valve insufficiency. Becker PS, Clavell LA, Beardsley DS. J. Pediatr. Hematol. Oncol. January 1998;20:69–73. Quote: Purpose: To study the platelets from a family with a new form of inherited giant platelet disorder. Patients and Methods: Two siblings exhibited a hemorrhagic disorder characterized by moderate thrombocytopenia, giant platelets, and markedly prolonged bleeding time. The parents had no discernible platelet defect. Both children also developed mitral regurgitation requiring medication, and one underwent surgical replacement at the age of 3 years. Results: The mean platelet size was greater than 20 μm3. Direct measurements of the two major axes of each of 12 platelets on electron micrographs revealed a range of 2×4 to 4×6 μm. Electron microscopy did not demonstrate any abnormality of granule content. The platelets agglutinated normally with ristocetin and aggregated normally with collagen. However, the aggregation was slightly slower than normal with ADP, epinephrine, and Na arachidonate. Two-dimensional unreduced versus reduced SDS-polyacrylamide gel electrophoresis of surface radioiodinated platelet glycoproteins revealed absence of proteins Ia, Ic, and IIa in both affected children, whereas GP Ib, IIb, and IIa appeared normal. The 2D gels of platelet glycoproteins from both parents were identical to controls. Western blots demonstrated that GP Ic, Ic', Ib, and Ia/IIa were present. Conclusions: This disorder represents a new syndrome of thrombocytopenia with giant platelets distinct from Bernard-Soulier, Montreal giant platelets, Swiss cheese platelets, May-Hegglin anomaly, and other previously described syndromes.
Platelet Counts in Cavalier King Charles Spaniels. Antech Diagnostics News, July 1998.
Control of Canine Genetic Diseases. Padgett, G. A., Howell Book House 1998, pp. 198-199, 223.
Hypomagnesemia and mitral valve prolapse in Cavalier King Charles spaniels. Pedersen HD, Mow T.; Zentralbl Veterinarmed A. 1998 Dec;45(10):607-14. Quote: "There is a high incidence of mitral valve prolapse (MVP), an abnormal displacement of one or both mitral valve leaflets during systole, in Cavalier King Charles Spaniels (CKCS). In humans, MVP is known to be associated with a low magnesium status. In this study, the plasma magnesium concentration was measured in 30 CKCS without heart failure. It was also investigated whether MVP-severity and degree of regurgitation correlated with plasma magnesium and a number of parameters of the renin-angiotensin system, and whether 4 weeks magnesium supplementation affected plasma magnesium or the high renin/low aldosterone profile associated with MVP. A high prevalence of hypomagnesemia was observed: plasma concentrations < 0.70 mmol/l were found in 15 dogs (50%) before and in 12 dogs (40%) after 4 weeks magnesium supplementation. The mean plasma level was 0.69 ± 0.07 mmol/l before and 0.71 + 0.07 mmol/l after magnesium (P = 0.22). Plasma magnesium concentrations did not correlate with MVP-severity and degree of regurgitation. Plasma aldosterone levels correlated negatively with MVP-severity and positively with the degree of regurgitation, and serum angiotensin-converting enzyme activities correlated negatively with the degree of regurgitation. Magnesium supplementation had no effects on renin and aldosterone nor on the ratio between the two. In conclusion, many CKCS without heart failure have hypomagnesemia whether they are fed supplementary magnesium or not - a finding which may be associated with the high prevalence of MVP in this breed. Further studies, however, are needed to clarify the role of a low magnesium status in canine MVP."
Increased platelet aggregation response in Cavalier King Charles spaniels with mitral valve prolapse. Olsen,L.H., Kristensen, A. T., Häggström, J., Jensen, A. L., Klitgaard, B., Hansson, H., Pedersen, H. D. J.Vet.Int.Med. 2001;15:209-216. Quote: "In Cavalier King Charles Spaniels (CKCS), a breed predisposed to myxomatous mitral valve disease, there is a high prevalence of hypomagnesemia and platelet anomalies, such as thrombocytopenia and macrothrombocytosis. The objective of this study was to evaluate platelet aggregation responses in CKCS and to determine the relationship between the platelet aggregation response and serum magnesium concentration, MVP, mitral regurgitation (MR), and platelet count. ... In conclusion, CKCS with MVP appeared to separate into 2 groups—1 group with <100,000 platelets/μL, normal platelet aggregation, low serum magnesium concentration, and enlarged platelets, and another group with >100,000 platelets/μL, increased platelet aggregation, and normal serum magnesium concentration and platelet size."
Idiopathic asymptomatic thrombocytopenia in Cavalier King Charles Spaniels is an autosomal recessive trait. Pedersen HD, Häggström J, Olsen LH, Christensen K, Selin A, Burmeister ML, Larsen H. J Vet Intern Med 2002;16(2):169-73. Quote: "Cavalier King Charles Spaniels (CKCS) often have idiopathic asymptomatic thrombocytopenia. In affected dogs, the thrombocytes often are large, and it has been speculated that the condition could be an inherited macrothrombocytopenia. The aim of this study was to examine the inheritance of idiopathic, asymptomatic thrombocytopenia in CKCS. Sixteen families (both parents and ≥3 offspring) of privately owned CKCS were included. There were 105 clinically healthy dogs (50 from Denmark and 55 from Sweden): 81 offspring and 26 parents (2 dogs had both roles). Because autoanalyzers have difficulty counting large platelets, the platelets were counted manually, with a counting chamber. Platelet counts were not influenced by age, gender, or heart murmur status. Thrombocytopenia (≤100,000 platelets/|μL) was found in 46% of the parents. The pedigrees indicated that thrombocytopenia segregated as an autosomal recessive trait and that 100,000 platelets/|μL was appropriate as a lower limit of normal. Affected offspring were found in all families, showing that all of the included parents were at least carriers. Therefore, the expected segregation ratios (which were in good accordance with the observed ones) were 1:0, 1:1, and 1:3 for the 3 crosses: affected X affected, normal X affected, and normal X normal. Within a given cross, the mean parental platelet count had no influence on the platelet counts of the offspring. We conclude that idiopathic, asymptomatic thrombocytopenia in CKCS is inherited in an autosomal recessive manner. The condition most likely constitutes an inherited macrothrombocytopenia in dogs."
Intact Primary Hemostatic Responses in Cavalier King Charles Spaniels with Macrothrombocytopenia. AT Kristensen, H Texel, HD Pedersen. J Vet Intern Med 2002; 16:348 (#85). Quote: “Cavalier King Charles Spaniels (CKCS) have a high prevalence of inherited macrothrombocytopenia with no apparent clinical signs of bleeding. In a study using platelet rich plasma and aggregometry thrombocytopenic CKCS did not have increased platelet responses. Recently a more physiologic method, the PFA-100 (Dade-Behring), has become available for evaluation of primary hemostatic function. ...This shows that primary hemostatic responses of CKCS are intact despite severe thrombocytopenia.”
Quantitative, functional, and morphologic characterization of platelets in the Cavalier King Charles spaniel. Cowan SM, Carroll RC, Gerard D, Bartges JW, et al. J Vet Intern Med 2002;16:349 (#90). Quote: "Thrombocytopenia and macrothrombocytes have been reported to occur in Cavalier King Charles Spaniels (CKCS), but the clinical characteristics of a thrombocytopathy in CKCS are unknown. The purposes of this study were to describe quantitative, functional, and morphological characteristics of platelets in the CKCS. Blood (25 ml) from 42 clinically normal CKCS was collected from the jugular vein and analyzed within 1 hour of collection. Automated platelet counts were obtained using citrate and EDTA as anticoagulants. Manual platelet counts were performed on EDTA blood in hemacytometer chambers, in duplicate, using phase contrast microscopy. Percent platelet aggregation in response to increasing concentrations of ADP (2, 4, 8, 16, 32 uM) was determined on platelet-rich plasma prepared from citrated blood. Standard, whole mount, and scanning electron microscopy (EM) was performed to examine internal morphology, distribution of dense granules, and platelet size. A cardiologist (REG) recorded the grade, character and site of murmurs. Thrombocytopenia ( 150,000/ul) using manual platelet counts was present in 29/42 dogs (69%). Average manual platelet count was 119,817/ul. One dog had platelet clumping and was excluded from analysis. There was a good correlation (r2 83%, p .001) between manual and automated platelet counts using EDTA, and a good correlation (r2 82, p .001) between manual and automated platelet counts using citrate. There were no significant differences in factors causing variation in platelet counts (specimen collection or handling, methodology, mean RBC volume, or PCV) in dogs that were thrombocytopenic. Twenty of forty-two dogs (48%) had cardiac murmurs. There was no correlation between thrombocytopenia and murmurs, sex, age, or hair coat color. There was no significant difference in percent aggregation in response to varying concentrations of ADP in CKCS with thrombocytopenia. There was also no significant difference in percent aggregation in CKCS with murmurs compared with those without murmurs. We conclude that EDTA or citrate can be used as anticoagulants for automated platelet counts in CKCS. There was no association of thrombocytopenia with murmurs, and no association of abnormal platelet aggregation with murmurs or thrombocytopenia. Further studies are underway to identify structural abnormalities in platelet morphology, granule content, or size in CKCS with thrombocytopenia."
Duncan & Prasse’s Veterinary Laboratory Medicine: Clinical Pathology. 4th ed. Latimer KS, Mahaffey EA, Prasse KW (eds). Iowa State Press, 2003, pp. 101-102, 114-116.
Decreased Platelet Function in Cavalier King Charles Spaniels with Mitral Valve Regurgitation. Tarnow I., Kristensen A. T., Texel H., Olsen L. H., Pedersen H. D. J Vet Intern Med. September 2003;17(5):680-686. Quote: With aggregometry, increased platelet activity has been reported in Cavalier King Charles Spaniels (CKCS) without mitral regurgitation (MR). In contrast, dogs with MR have been found to have decreased platelet activity. The purpose of this study was to test an easy bedside test of platelet function (the Platelet Function Analyzer [PFA-100t]) to see if it could detect an increase in platelet activity in CKCS without MR and a decrease in platelet activity in CKCS with MR. This study included 101 clinically healthy dogs .1 year of age: 15 control dogs of different breeds and 86 CKCS. None of the dogs received medication or had a history of bleeding. The PFA-100 evaluates platelet function in anticoagulated whole blood under high shear stress. Results are given as closure times (CT): the time it takes before a platelet plug occludes a hole in a membrane coated by agonists. The CT with collagen and adenosine-diphosphate as agonists was similar in control dogs (median 62 seconds; interquartile interval 55–66 seconds) and CKCS with no or minimal MR (55; 52–64 seconds). The CT was higher in CKCS with mild MR (regurgitant jet occupying 15–50% of the left atrial area) (75; 60–84 seconds; P 5 .0007) and in CKCS with moderate to severe MR (jet .50%) (87; 66–102 seconds; P , .0001). CKCS with mild, moderate, and severe, clinically inapparent MR have decreased platelet function. The previous finding of increased platelet reactivity in nonthrombocytopenic CKCS without MR could not be reproduced with the PFA-100 device.
Platelet Counts in Cavalier King Charles Spaniels. Antech Diagnostics News Lab Tips, Oct 2003.
Guide to Congenital and Heritable Disorders in Dogs. Dodds WJ, Hall S, Inks K, A.V.A.R., Jan 2004, Section II(311a).
Breed Predispositions to Disease in Dogs & Cats. Alex Gough, Alison Thomas. 2004; Blackwell Publ. 44-45.
Comparison of manual and automated methods for determining platelet counts in dogs with macrothrombocytopenia. Olsen LH, Kristensen AT, Qvortrup K, Pedersen HD; J Vet Diagn Invest, March 2004; 16:167-170. Quote: "Platelet counts were performed in 43 Cavalier King Charles Spaniels (CKCS), a breed predisposed to macrothrombocytopenia) and in 10 control dogs using 3 automated systems and 3 manual methods (erythrocyte-lysing agents + counting chamber or evaluation of blood smear). Good correlations were found between platelet counts using all methods (all P < 0.0001; R2 = 0.71-0.85). Best correlations were found between the manual methods. Significantly larger platelets were found in CKCS with platelet count < or = 100,000/microl when compared with control dogs and CKCS with platelet count > 100,000/microl (both P < 0.0001). All platelet counts--except when made with the 2 counting chamber methods--were underestimated at platelet counts < or = 100,000/microl."
Giant platelet disorder in the Cavalier King Charles Spaniel. Cowan SM, Bartges JW, Gompf RE, et al.; Exp Hem, April 2004; 32:344-350. Quote: "A benign inherited giant platelet disorder affects approximately 50% of Cavalier King Charles Spaniels. It is characterized by thrombocytopenia, macrothrombocytes, or decreased platelet aggregation in response to ADP. Platelet ultrastructure is normal. Citrated or EDTA blood provides accurate platelet counts. Further studies are indicated to determine platelet glycoprotein structure and any association with mitral endocardiosis. Cavaliers may be useful models of inherited giant platelet disorders."
Determinants of weak femoral artery pulse in dogs with mitral valve prolapse. I. Tarnow, L. H. Olsen, M. B. Jensen, K. M. Pedersen, H. D. Pedersen. Res, Vet, Sci. April 2004; doi: 10.1016/j.rvsc.2003.10.001. Quote: In three substudies encompassing 247 dogs from two breeds predisposed to myxomatous mitral valve disease (MMVD), femoral artery pulse strength was palpated and related to potential explanatory factors, including quantitative echocardiographic measures of MMVD, aortic and femoral artery diameter and wall thickness and blood pressure. In addition, in 109 Cavalier King Charles Spaniels (of which 61 were included in the three substudies mentioned above), the relation between femoral artery pulse strength and presence of thrombocytopenia was investigated. ... A weak femoral artery pulse is a common finding in CKCS. ... No relation, however, was found between presence of thrombocytopenia and femoral artery pulse strength in this study. ... In conclusion, this study demonstrated that a weak femoral artery pulse is a common finding in CKCS and Dachshunds, and that the pulse strength in any one dog is reasonably reproducible. Pulse strength was found to be inversely related to heart rate, degree of obesity and MVP severity. In addition, femoral artery pulse strength decreased with age. The weak femoral artery pulses appear to reflect a decrease in diastolic artery diameter and/or systolic distension associated with a local decrease in blood flow, not artery occlusion or changes in pulse pressure and stroke volume. ... In 26% of the dogs, a pulse ⩽50% of normal strength was detected; six dogs (2.0%) had an absent pulse unilaterally or bilaterally. Mitral valve prolapse severity, degree of obesity, heart rate and age all influenced femoral artery pulse strength negatively. Weak femoral artery pulses were not related to clinical signs or to decreased pulse pressure or stroke volume. A weak femoral artery pulse reflected reduced artery diameter and/or distension rather than occlusion. In conclusion, weak femoral artery pulses in dogs with MMVD seem to be associated with regional/local reductions in blood flow and not arteriosclerosis or platelet count.
Assessment of changes in hemostatic markers in Cavalier King Charles Spaniels with myxomatous mitral valve disease. Tarnow I, Kristensen AT, Olsen LH, Pedersen HD. Am J Vet Res. 2004 Dec;65(12):1644-52. Quote: "Objective - To evaluate markers of haemostasis and their relationship to the degree of mitral regurgitation (MR) and platelet function in Cavalier King Charles Spaniels (CKCSs) with myxomatous mitral valve disease. ... Conclusions and Clinical Relevance - In CKCSs, MR appeared to be associated with a low plasma vWF concentration and likely a loss of vWF HMWMs (possibly through their destruction via shear stress to the blood). The importance of the changes in plasma fibrinogen concentration and the thromboembolic risk in dogs with MR remain to be investigated."
Biomarkers of Platelet Activation in Cavalier King Charles Spaniels. D.F. Hogan, D.J. Weiss, C.A. Thompson, M.P. Ward. J Vet Intern Med; May/June 2005;19(3) (ACVIM 23rd Ann. Vet. Med. Forum Abstract Program: Abstract 175).
Platelets in Cavalier King Charles Spaniels. Antech Diagnostics News Lab Tips, June 2005.
Dogs with Heart Diseases Causing Turbulent High-Velocity Blood Flow Have Changes in Platelet Function and von Willebrand Factor Multimer Distribution. Tarnow I., Kristensen A. T., Olsen L. H., Falk T., Haubro L., Pedersen L. G., Pedersen H. G.; J Vet Intern Med. 2005 Jul;19(4):515-521. Quote: "The purpose of this prospective study was to investigate platelet function using in vitro tests based on both high and low shear rates and von Willebrand factor (vWf) multimeric composition in dogs with cardiac disease and turbulent high-velocity blood flow. Client-owned asymptomatic, untreated dogs were divided into 4 groups: 14 Cavalier King Charles Spaniels (Cavaliers) with mitral valve prolapse (MVP) and no or minimal mitral regurgitation (MR), 17 Cavaliers with MVP and moderate to severe MR, 14 control dogs, and 10 dogs with subaortic stenosis (SAS). Clinical examinations and echocardiography were performed in all dogs. PFA100 closure times (the ability of platelets to occlude a hole in a membrane at high shear rates), platelet activation markers (plasma thromboxane B2 concentration, platelet surface P-selectin expression), platelet aggregation (in whole blood and platelet-rich plasma with 3 different agonists), and vWf multimers were analyzed. Cavaliers with moderate to severe MR and dogs with SAS had longer closure times and a lower percentage of the largest vWf multimers than did controls. Maximal aggregation responses were unchanged in dogs with SAS but enhanced in Cavaliers with MVP (regardless of MR status) compared with control dogs. No significant difference in platelet activation markers was found among groups. The data suggest that a form of platelet dysfunction detected at high shear rates was present in dogs with MR and SAS, possibly associated with a qualitative vWf defect. Aggregation results suggest increased platelet reactivity in Cavaliers, but the platelets did not appear to circulate in a preactivated state in either disease."
Idiopathic thrombocytopenia in Cavalier King Charles Spaniels. Singh M. K., Lamb W. A. Aust Vet J. 2005 Nov;83(11):700-3. Quote: "It has been shown that Cavalier King Charles Spaniels (CKCS) in Sweden and Denmark have a high prevalence of idiopathic thrombocytopaenia without bleeding tendencies and that the syndrome has an autosomal recessive inheritance pattern. A similar thrombocytopaenia has been observed in New South Wales (NSW). The purpose of this study was to determine the prevalence of asymptomatic idiopathic macrothrombocytopaenia in the population of CKCS in NSW and to determine if it exhibits an autosomal recessive inheritance pattern. We also aimed to determine if significant differences existed when counting platelets manually, by auto analyser or by blood smear estimation in CKCS and mixed breed dogs. Blood was collected from 172 dogs (152 CKCS and 20 mixed breed) and placed into sodium-citrate anticoagulant. Platelet counts were performed manually, by auto analyser and by blood smear estimates in CKCS and mixed breed dogs. Blood smears were also examined for platelet clumping and morphology as well as erythrocyte and leukocyte morphology. Pedigree analysis was performed to determine if an autosomal recessive inheritance pattern was supported. A statistically significant difference was found in platelet counts between CKCS and mixed breed dogs (P < 0.0001). CKCS had a platelet count that was 32% that of the controls (95% confidence interval = 28 to 37%). If the lower limit of normal was set at 200 x 109/L, the prevalence of thrombocytopaenia in CKCS was 90% with 25% having severe thrombocytopaenia (<50 x 109/L). There was no significant difference between methods used to count platelets. Thirty percent of CKCS had macrothrombocytes. Pedigree analysis and examination of obtained and expected segregation ratios from 17 CKCS families supported an autosomal recessive pattern of Mendelian inheritance."
Macrothrombocytopenia in the Cavalier King Charles Spaniel. Meg Carriere, DVM; Kenneth S. Latimer, DVM, PhD; Bruce E. LeRoy, DVM, PhD; Heather L. Tarpley, DVM. College of Veterinary Medicine, Univ. of Georgia. 2006. www.vet.uga.edu/vpp/clerk/carriere/index.php
Platelet function in dogs: breed differences and effect of acetylsalicylic acid administration. Line A. Nielsen, Nora E. Zois, Henrik D. Pedersen, Lisbeth H. Olsen, Inge Tarnow. Veterinary Clinical Pathology. September 2007;36(3):267-273. Quote: "Background: Clinical studies investigating platelet function in dogs have had conflicting results that may be caused by normal physiologic variation in platelet response to agonists. Objectives: The objective of this study was to investigate platelet function in clinically healthy dogs of 4 different breeds by whole-blood aggregometry and with a point-of-care platelet function analyzer (PFA-100), and to evaluate the effect of acetylsalicylic acid (ASA) administration on the results from both methods. Methods: Forty-five clinically healthy dogs (12 Cavalier King Charles Spaniels [CKCS], 12 Cairn Terriers, 10 Boxers, and 11 Labrador Retrievers) were included in the study. Platelet function was assessed by whole-blood aggregation with ADP (1, 5, 10, and 20 μM) as agonist and by PFA-100 using collagen and epinephrine (Col + Epi) and Col + ADP as agonists. Plasma thromboxane B2 concentration was determined by an enzyme immunoassay. To investigate the effect of ASA, 10 dogs were dosed daily (75 or 250 mg ASA orally) for 4 consecutive days. Results: A higher platelet aggregation response was found in CKCS compared to the other breeds. Longer PFA-100 closure time (Col + Epi) was found in Cairn Terriers compared to Boxers. Plasma thromboxane B2 concentration was not statistically different between groups. Administration of ASA prolonged the PFA-100 closure times, using Col + Epi (but not Col + ADP) as agonists. Furthermore, ASA resulted in a decrease in whole-blood platelet aggregation. Conclusions: Platelet function is influenced by breed, depending upon the methodology applied. However, the importance of these breed differences remains to be investigated. The PFA-100 method with Col + Epi as agonists, and ADP-induced platelet aggregation appear to be sensitive to ASA in dogs."
Comparison of methods for determining platelet numbers and volume in cavalier King Charles spaniels. W. Bertazzolo, S. Comazzi, L. Sesso, P. Scarpa, G. Ru, S. Paltrinieri. J Small Animal Practice, Oct 2007;48(10):556-561. Quote: "CKCS with macrothrombocytosis have low platelet counts on impedance cell counters, laser cell counters and microscopic estimation. CKCS with low platelet counts may have a normal platelet crit detected by a quantitative buffy coat analyser and thus a normal circulating platelet mass."
The molecular basis for inherited macrothrombocytopenia in Cavalier King Charles Spaniels: Genetic Insight into Blood Disorder. Jennifer Brooke Davis. Morris Animal Foundation Study ID: D06CA-611. Quote: "The focus of this study was the role of a protein found in healthy, mature platelets. Through analysis of this protein, the researchers were able to identify a genetic mutation in the protein of dogs affected. This finding could help researchers design a more precise test for certain platelet disorders, ultimately eliminating them through responsible breeding. The ability to distinguish acquired from genetic forms of diseases also will help researchers to more precisely design their treatments and avoid use of unnecessary steroids, antibiotics or other medications."
Mutation in β1-Tubulin Correlates with Macrothrombocytopenia in Cavalier King Charles Spaniels. B. Davis, M. Toivio-Kinnucan, S. Schuller, M.K. Boudreaux. J.Vet.Int.Med. May-June 2008;22(3): 540-545. Quote: "Background: Cavalier King Charles Spaniels (CKCS) have a high prevalence of inherited macrothrombocytopenia. The purpose of this study was to determine if a mutation in β1-tubulin correlated with presumptive inherited macrothrombocytopenia. Hypothesis: A mutation in β1-tubulin results in synthesis of an altered β1-tubulin monomer. α-β tubulin dimers within microtubule protofilaments are unstable, resulting in altered megakaryocyte proplatelet formation. ... Methods: DNA was used in polymerase chain reaction (PCR) assays to evaluate β1-tubulin. Platelet numbers and mean platelet volume (MPV) were evaluated for a correlation with the presence or absence of a mutation identified in β1-tubulin. Platelets obtained from homozygous, heterozygous, and clear CKCS were further evaluated using electron microscopy and immunofluorescence. Results: A mutation in the gene encoding β1-tubulin correlated with macrothrombocytopenia in CKCS. Electron microscopy and immunofluorescence studies suggest that platelet microtubules are present but most likely are unstable and decreased in number. Conclusions and Clinical Importance: The macrothrombocytopenia of CKCS correlated with a mutation in β1-tubulin. α–β tubulin dimers within protofilaments most likely are unstable, leading to altered proplatelet formation by megakaryocytes. This information will aid in distinguishing inherited from acquired thrombocytopenia. It also provides insight into the mechanism of platelet production by megakaryocytes, and also may prove useful in understanding heart-related changes in macrothrombo-cytopenic CKCS with concurrent mitral valve regurgitation."
Plateletcrit is superior to platelet count for assessing platelet status in Cavalier King Charles Spaniels. Harold Tvedten, Inger Lilliehöök, Anna Hillström, Jens Häggström. Vet. Clinical Pathology; July 2008; 37(3): 266-271. Quote: "Many Cavalier King Charles Spaniel (CKCS) dogs are affected by an autosomal recessive dysplasia of platelets resulting in fewer but larger platelets. The IDEXX Vet Autoread (QBC) hematology analyzer directly measures the relative volume of platelets in a blood sample (plateletcrit). We hypothesized that CKCS both with and without hereditary macrothrombocytosis would have a normal plateletcrit and that the QBC results would better identify the total circulating volume of platelets in CKCS than methods directly enumerating platelet numbers. Objectives: The major purpose of this study was to compare the QBC platelet results with platelet counts from other automated and manual methods for evaluating platelet status in CKCS dogs. ... The IDEXX Vet Autoread (QBC) hematology analyzer directly measures the relative volume of platelets in a blood sample (plateletcrit). ... The major purpose of this study was to compare the QBC platelet results with platelet counts from other automated and manual methods for evaluating platelet status in CKCS dogs. ... Results: None of the 27 CKCS dogs had thrombocytopenia (defined as <164 × 109 platelets/L) based on the QBC platelet count. Fourteen (52%) to 18 (66%) of the dogs had thrombocytopenia with other methods. The percentage of large platelets, as determined by regating the Sysmex optical platelet counts, ranged from 1% to 75%, in a gradual continuum. Conclusions: The QBC may be the best analyzer for assessing clinically relevant thrombocytopenia in CKCS dogs, because its platelet count is based on the plateletcrit, a measurement of platelet mass."
Platelet distribution width and mean platelet volume in the interpretation of thrombocytopenia in dogs. N. X. Bommer, D. J. Shaw, E. M. Milne, A. E. Ridyard. J.Sm.An.Prac.;Oct 2008;49(10):518-524. Quote: "Objectives: To investigate the use of platelet volume indices in the interpretation of thrombocytopenia in dogs with systemic disease. Methods: Case records of 80 control dogs and 159 thrombocytopenic dogs with systemic disease were reviewed retrospectively. ... Cavalier King Charles spaniels were excluded from all groups because of known breed- related macrothrombocytopenia. ... The relationships between mean platelet volume, platelet distribution width and platelet count in systemically well dogs were established. Knowledge of these relationships was used to interpret thrombocytopenia in terms of the underlying disease process. Results: There was a positive relationship between platelet distribution width and mean platelet volume. Both platelet distribution width and mean platelet volume varied in a negative relationship with platelet count, which was unaffected by signalment, underlying disease, variations in haematological parameters or serum proteins. Clinical Significance: The interpretation of mean platelet volume and platelet distribution width in dogs requires simultaneous reference to the platelet count. Platelet volume indices did not aid interpretation of thrombocytopenia in terms of underlying pathological processes in the population studied."
Updates in clinical pathology: Macrothrombocytopaenia in Cavalier King Charles Spaniels. Size matters! Sarah Putwain. Companion Animal Oct 2009 14(8):36-38.
Insights into Serotonin Signaling Mechanisms Associated with Canine Degenerative Mitral Valve Disease. M.A. Oyama and R.J. Levy. J Vet Intern Med Jan/Feb 2010;24:27–36. Quote: "In Cavalier King Charles Spaniels, the time from onset of a heart murmur to death because of congestive heart failure can be quite accelerated, highlighting the rapid nature of disease progression in this particular breed. ... Putative sources of heightened 5HT (serotonin) signaling in dogs with DMVD include increased circulating or platelet-derived 5HT,increased autocrine 5HT production, or valvular SERT deficiency. We have previously reported increased serum 5HT concentrations in dogs with DMVD (degenerative mitral valve disease). Serum 5HT was increased by approximately 50% in dogs with DMVD as well as in small breed dogs predisposed to DMVD as compared with healthy large breed control dogs. Interestingly, Cavalier King Charles Spaniels, which are highly predisposed to DMVD as well as macrothrombocytosis, had significantly higher serum 5HT concentrations than did other breeds of dogs. In general, measurement of serum 5HT encompasses 2 different sources, platelet-stored 5HT and plasma 5HT, of which platelet 5HT is the much larger source. The hypothesis that platelet-derived 5HT directly activates myocardial or valvular fibroblasts is supported by Yabanoglu et al who reported chemotaxis of platelets to regions of cardiac damage, with subsequent 5HT release, fibroblast differentiation, and production of TGF-b1 and matrix metalloproteinases. This effect was inhibited by co-administration of ketanserin, a 5HT–R2Aspecific blocking agent, again suggesting that this receptor plays an important role in the activation of cardiac fibroblasts by 5HT. This study is important insofar as it supports a key hypothesis involving direct interaction among platelets, platelet-derived 5HT, 5HT receptors, increased 5HT and TGF-β1 signaling, and subsequent cardiac cell differentiation."
Thromboelastography in Dogs with Asymptomaticmyxomatous Mitral Valve Disease. I Tarnow, LH Olsen, SG Moesgaard, AU Martinsen, AC Birkegaard, AT Kristensen, B Wiinberg. J Vet Intern Med 2010;24:--- (ACVIM 28th Ann. Vet. Med. Forum Abstract Program: Abstract 11). Quote: "Changes in platelet aggregation responses and von Willebrand factor multimer levels have been reported in dogs with asymptomatic heart disease. Alterations in hemostatic pathways may be involved in the progression of canine mitral valve disease by causing microthrombosis and vessel changes in the myocardium, and it is being debated whether dogs with heart disease could benefit from antithrombotic therapy. We hypothesized that a global hypercoagulability is present in dogs with asymptomatic mitral valve disease. The study investigated Kaolin and Tissue Factor activated thromboelastographic (TEG) tracings in 3 groups of dogs: 11 Cavalier King Charles Spaniels (CKCS) with no or minimal mitral regurgitation (MR) (age 5.0 1.8 years), 14 CKCS with severe MR (regurgitant jet size by echocardio-graphy 50%) (age 7.1 1.6 years), and 8 healthy Beagles with no or minimal MR (age 7.7 2.3 years). ... These data do not support the hypothesis that a global hypercoagulability is present in CKCS with asymptomatic myxomatous mitral valve disease. Moreover, prospective longitudinal trials are needed to demonstrate a benefit of anti-thrombotic therapy in dogs with asymptomatic heart disease. The data supports previous findings that CKCS with macrothrombocytopenia have a normal coagulation response despite low platelet counts."
Breed Predispositions to Disease in Dogs & Cats (2d Ed.). Alex Gough, Alison Thomas. 2010; Wiley-Blackwell Publ. 54.
Genetic Connection: A Guide to Health Problems in Purebred Dogs, Second Edition. Lowell Ackerman. July 2011; AAHA Press; pg 88. Quote: "An asymptomatic thrombocytipenia typically, but not always, associated with large to giant platelets has been reported in the Cavalier King Charles spaniel. The condition, macrothrombocytopenia, has been reported as an autosomal recessive trait in the breed, and the molecular basis for the condition is a mutation in the gene encoding β-1 tubulin. The diagnosis should be suspected when thrombocytopenia and large platelets are reported in this breed without evidence of bleeding diathesis. No treatment is necessary. Despite the fact that this disorder appears to be asymptomatic, it would seem prudent not to use affected animals for breeding. Genetic testing is now available for identifying affected, carrier, and clear individuals."
Inherited platelet disorders. Mary K. Boudreaux. J.Vet.Emer. & Crit. Care. Jan.2012.
Validation of Advia plateletcrit for assessing platelet mass in dogs, including Cavalier King Charles Spaniels. Harold W. Tvedten, Inger E. Lilliehöök, Josefine Öberg, Jens Häggström, Katja Höglund and Ingrid Ljungvall. Vety. Clinical Pathology.Sept 2012;41(3):336-343. Quote: "Background: Determination of the plateletcrit (PCT) is the most effective way to evaluate platelet mass in dogs, such as Cavalier King Charles spaniel (CKCS) dogs, with macrothrombocytopenia. The IDEXX VetAutoread hematology analyzer, which performs quantitative buffy coat (QBC) analysis, has been validated to determine platelet mass in CKCS dogs. The Advia 2120 reports a PCT, but the validity of this value has not been evaluated for dogs with macrothrombocytopenia. Objectives: The goal of this study was to validate MPV and PCT determined by the Advia 2120 in dogs, including CKCS dogs, comparing values with those obtained from QBC analysis. Methods: Advia PCT was compared with QBC results from 43 CKCS dogs and 15 dogs of other breeds in one study. Advia PCT, platelet count, and MPV were evaluated to identify biologic patterns in 31 clinically healthy CKCS dogs and 66 dogs of 3 other breeds and to generate values used for comparisons. Results: Advia PCT agreed well with QBC results in general, but had a negative bias and appeared to underestimate PCT in CKCS dogs with the lowest PCTs. Advia PCT and MPV results followed expected biologic patterns in CKCS dogs and dogs of other breeds with MPVs being highest in dogs with the lowest platelet counts. Conclusions: Advia 2120 PCT and MPV satisfactorily identified changes in platelet mass and size in CKCS dogs, but PCTs were lower than expected, especially in CKCS dogs with the lowest PCTs, when compared with QBC results."
Macrothrombocytopenia in a Cavalier King Charles Spaniel. Sarah Schmidt & Joyce S. Knoll. Clinician's Brief. Dec. 2012;10(12):31-34. Quote: "History: The Cavalier King Charles spaniel (CKCS) had a previous diagnosis of a grade III/VI left systolic heart murmur. Physical Examination: The heart murmur as previously described was detected. Instability in the left stifle was also noted. The remainder of the examination was unremarkable. Laboratory Evaluation: CBC was unremarkable with the exception of an automated platelet count of 2350/μL (reference interval, 181–525 ¥ 103/μL; Cell-Dyn 3500 hematology analyzer [abbott.com] using impedance technology for platelet count). A blood smear was evaluated. Diagnosis: ... It is important to note that these dogs may mistakenly be considered to have an underlying disease that results in thrombocytopenia, such as immune-mediated thrombocytopenia, tick-borne infection, or a bone marrow disorder. Unlike other dogs with platelet counts of 30,000/μL or lower, CKCSs with the mutation do not have signs of spontaneous mucocutaneous hemorrhage because their overall platelet function is normal. Platelet function is believed to depend more on total platelet mass (number × volume) than platelet number alone. The platelet mass of CKCSs with inherited macrothrombocytopenia is reportedly similar to CKCSs without the mutation (normal platelet count and no large platelets). ... Follow-up: As the dog did not have signs to suggest an underlying bleeding disorder or a hyper coagulative state, thrombocytopenia and macroplatelets were presumed to be a result of inherited macrothrombocytopenia. The dog was also diagnosed with a cranial cruciate tear of the left stifle."
Platelet count and plateletcrit in Cavalier King Charles Spaniels and Greyhounds using the Advia 120/2120. Jessica Anne Kelley. Univ. of Minn. Digital Conservancy. Jan. 2013. MS thesis. Quote: "This thesis investigates the use of the plateletcrit as an assessment of total platelet biomass in Cavalier King Charles Spaniels with asymptomatic congenital macrothrombocytopenia. ... Background: Models for the regulation of thrombopoiesis predict that platelet mass is the biologically regulated parameter, yet clinical evaluations are often based on platelet number. When there is concurrent thrombocytopenia and variation in platelet size, platelet count may poorly estimate total platelet mass, confounding clinical decision making. Objective: We hypothesize that plateletcrit provides clinically important information when platelet number is an incomplete representation of platelet mass, such as in genetic macrothrombocytopenia. Methods: We retrospectively compared platelet count and plateletcrits with general reference intervals for four groups of dogs: sick Cavalier King Charles Spaniels and Greyhounds that presented for non-hematopoietic disease to the University of Minnesota (Advia 2120) and Auburn University Teaching Hospitals (Advia 120) over a 3 year period. Results: A canine plateletcrit reference interval of 0.129 – 0.403 % was established. None of the four sample groups were found to have significantly more individuals below the reference interval for plateletcit. For platelet count, only the Cavalier groups were found to have significantly more individuals below the reference interval than predicted. Conclusion: Use of the plateletcrit as determined by the Advia 120/2120 appeared to avoid overestimation of low platelet mass in sick Cavalier Kind Charles Spaniels in a clinical setting. In contrast, the plateletcrit performed similarly to the platelet count in evaluation of platelet mass in sick Greyhounds. ... In this particular model of an inherited asymptomatic macrothrombocytopenic platelet disorder, Cavalier King Charles Spaniels represent a group of individuals in which the bleeding risk is better evaluated using plateletcrit than platelet number. The platelet mass appears significantly lower in affected dogs when measured by count, but when measured by plateletcrit, more of the patients are appropriately within the reference range. Therefore, for the Cavalier King Charles Spaniels affected by this mutation, plateletcrit better represents the true total platelet biomass in peripheral circulation." (See also, published version of this article, below.)
In vitro effect of pimobendan on platelet aggregation in dogs. Eryn A. Shipley, Daniel F. Hogan, Nonya N. Fiakpui, Aliya N. Magee, Henry W. Green III, Kimberly A. Sederquist. Amer,J,Vety.Res. March 2013. 74(3):403-407. Quote: "Objective: To determine whether pimobendan has in vitro antithrombotic properties through inhibition of platelets in canine blood samples. Animals: 10 healthy adult dogs. ... Results: Compared with findings for 0.0μM pimobendan, composite platelet aggregation (area under the curve [AUC]) and maximal platelet aggregation (aggregation units [AUs]) at 10.0μM pimobendan were significantly decreased for collagen-induced aggregation (AUC, 349.7 ± 58.4 vs 285.1 ± 72.2; maximal platelet aggregation, 196.2 ± 25.8 AUs vs 161.5 ± 38.0 AUs), and the AUC and velocity of aggregation at 10.0μM pimobendan were significantly decreased for ADP-induced aggregation (AUC, 268.5 ± 35.1 vs 213.4 ± 77.2; velocity of aggregation, 15.7 ± 2.9 AUs/min vs 11.8 ± 3.5 AUs/min). Pimobendan had no significant effect on plasma thromboxane concentration or thromboelastographic variables, regardless of concentration. Conclusions and Clinical Relevance: In vitro, pimobendan had an antiplatelet effect in canine blood samples at a concentration 1,000-fold higher than that clinically achievable. These antiplatelet properties do not appear to contribute to the positive clinical profile of the drug in dogs. Pimobendan administration would not appear to confer a risk for bleeding and does not have to be avoided in dogs with thrombocytopenia or those concurrently receiving antiplatelet drugs."
Platelet count and plateletcrit in Cavalier King Charles Spaniels and Greyhounds using the Advia 120 and 2120. Jessica Kelley, Leslie C. Sharkey, Pete W. Christopherson, Aaron Rendahl. Vet. Clinical Pathology. March 2014;43(1):43-49. Quote: "Background: Models for the regulation of thrombopoiesis predict that platelet mass is the biologically regulated variable, yet clinical evaluations of thrombopoiesis are often based on platelet number. When thrombocytopenia and variation in platelet size occur concurrently, platelet count may poorly estimate total platelet mass, confounding clinical decision making. Objective: We hypothesized that plateletcrit (PCT) provides clinically important information when platelet number is an incomplete representation of platelet mass, such as in genetic macrothrombocytopenia. Methods: We retrospectively compared platelet count and PCTs with general reference intervals for 4 groups of dogs: sick Cavalier King Charles Spaniels (CKCS) and Greyhounds, presented for nonhematopoietic disease to the University of Minnesota (measured using an Advia 2120) and Auburn University Teaching Hospitals (measured using an Advia 120) over a 3-year period. Results: A canine PCT reference interval of 0.129–0.403% was established. None of the 4 sample groups had significantly more individuals below the reference interval for plateletcrit. For platelet count, only the 2 CKCS groups had significantly more individuals below the reference interval than predicted. Conclusion: Use of the PCT as determined by the Advia 120/2120 appeared to avoid overestimation of low platelet mass in sick CKCS in a clinical setting. In contrast, the PCT performed similarly to the platelet count in evaluation of platelet mass in sick Greyhounds. Evaluation of the PCT should be considered in other conditions associated with increased mean platelet volume." (See also, Ms. Kelley's MS thesis, above.)
High-level serotonin-binding in subpopulation of highly-activated platelets in cavalier King Charles spaniels with myxomatous mitral valve disease. S.E. Cremer, A.T. Kristensen, M.J. Reimann, N.B. Eriksen, S.F. Petersen, C.B. Marschner, I. Tarnow, M.A. Oyama, L.H. Olsen. J.Vet.Int.Med. Apr. 2014;28(3):1002. Quote: "Circulating (platelet-derived) serotonin (5HT) concentration is elevated in early stages of myxomatous mitral valve disease (MMVD) in Cavalier King Charles Spaniels (CKCS). CKCS are predisposed to early-onset MMVD and approximately 33% exhibit non-clinical macrothrombocytopenia (TCP). By means of flow cytometry, we investigated percent (%) and level (mean-fluorescence-intensity/MFI) of platelet-activation (CD62 surface expression) and surface-bound 5HT in platelet rich plasma (PRP) in CKCS with MMVD. Dogs with TCP were included, but only normal-size platelets were analyzed. Effect of disease-group, age, gender, body weight, hematocrit and TCP were included in multiple linear regression analyses. Disease-groups (assessed echocardiographically) were: healthy (n = 14), mild MMVD (n = 18), moderate-severe MMVD (n = 19) and severe MMVD in treatment for heart-failure (n = 10). There was an overall difference in level of platelet-activation (P = 0.04) with a tendency to higher activation level in moderate-severe MMVD (1661MFI (1356-2379)) (median (interquartile range)) and heart-failure (1452MFI (989-3242)) compared to healthy dogs (1325MFI (904-2505) (both P = 0.07)). In 28 dogs, a subpopulation of platelets with high 5HT-binding (5HT-P) was identified. These dogs (compared to non-5HT-P dogs) had higher percent of 5HT-positive platelets (10.4% (7.8-15.4) versus 5.7% (3.3-8.6), P < 0.0001), 5HT-binding level (30360MFI (26400-39260) versus 1230MFI (810-2830), P < 0.0001) and platelet-activation level (2360MFI (1520-2830) versus 1170MFI (890-1360), (P = 0.002). 5HT-P were present in 93.8% of dogs with TCP and in 29.6% of non-TCP dogs. In conclusion, a potential association between level of platelet activation and MMVD-severity was found. Interestingly, a highly-activated platelet subpopulation with high-level 5HT-binding was identified and strongly associated with TCP. Further investigation into significance of 5HT-P in CKCS is warranted."
Immune Mediated Thrombocytopenia, Diagnosis And recent Advancement in its Treatment in Dogs - A Review. Muhammad Ahsan Naeem, Bilal Aslam, Ahmad Raza, Tanweer Kaliq,Ijaz Javed Hasan, Junaid Ali Khan, Asghar Ali, Shamshad ul Hassan and Zainab Kaleem. Indo American J. Pharm Research. July 2014:4(07). Quote: "Mononuclear phagocytic system causes the elimination of platelets with the help of antibodies and as result immune mediated thrombocytopenia (IMT), which there is activation of auto- or allo-antiglobulins against thrombocytes leads to its premature destruction by macrophagic engulfment in dogs. Immune system due to presence of other disorder my cause the destruction of platelets so by confirming the absence of secondary disorder is an evidence that immune system is responsible for causing destruction of platelets and this type of thrombocytopenia is primary immune mediated thrombocytopenia and it can be treated by suppressing immune system with the help of immune suppressive therapy while the thrombocytopenia caused by presence of any other disorder is secondary immune mediated thrombocytopenia which can be treated by removing that disorder which is responsible or due to which this type of immune mediated thrombocytopenia has been occurred or we can also give immune suppressive drug. If dogs suffering from immune mediated thrombocytopenia do not show any response to the therapy then additional immunotherapy can be given and in some cases the examination is repeated again in order to find out any other cause involved which may be left to be identified. ... A severe, inherited thrombocytopenia has been reported to occur in up to 50% of Cavalier King Charles spaniels. Platelet counts can be as low as 20,000/μl, but many affected dogs have macrothrombocytes, and this disorder is not associated with a bleeding tendency. Perform manual platelet counts in dogs of this breed with thrombocytopenia, as large platelets may result in falsely low platelet counts as measured by impedance analyzers."
Serotonin concentration is elevated in platelet rich plasma and left ventricular myocardial and mitral valve leaflet tissue in dogs with myxomatous mitral valve disease. S.E. Cremer, G.E. Singletary, L.H. Olsen, K. Wallace, J. Häggström, I. Ljungvall, K. Höglund, C.A. Reynolds, N. Pizzinat, M.A. Oyama. J.Vet.Int.Med. July 2014;28(4):1351. Quote: "Heightened serotonin (5HT) signaling is postulated in the development and/or progression of myxomatous mitral valve disease (MMVD) in dogs. Little is known regarding platelet, myocardial, or valvular 5HT concentration ([5HT]) in affected dogs. We sought to quantify [5HT] in platelet-rich (PRP), platelet-poor plasma (PPP), left ventricular myocardium (LV), and mitral valve leaflet tissue (MV) using HPLC. PPP/PRP was prepared from 45 dogs comprising 4 different plasma groups (pG1, healthy non-Cavalier King Charles Spaniels [CKCS], n = 8; pG2, healthy CKCS, n = 12; pG3, MMVD CKCS, n = 14; pG4, MMVD non-CKCS, n = 11). PRP [5HT] was greater than PPP [5HT] (P < 0.0001) indicating platelets as the primary source of circulating 5HT. Median PRP platelet [5HT] was significantly different between groups (P = 0.003). PRP [5HT] was greater in pG2 (1.83 femtograms/platelet[range,0.2-4.76];P = 0.002), pG3 (1.58,0.70-4.03;P = 0.005), and pG4 (1.72,0.85-4.44;P = 0.003) vs. pG1 (0.915,0.63-1.3). There was no significant difference in median PPP [5HT] between groups. At euthanasia, LV and MV tissue was obtained from 24 dogs comprising 3 different tissue groups (tG1, MMVD, n = 8; tG2, dilated cardiomyopathy [DCM]/arrhythmogenic right ventricular cardiomyopathy [ARVC], n = 7; tG3, extra-cardiac disease, n = 9). Median LV [5HT] was significantly different (P = 0.0024) between groups. LV [5HT] was higher in tG1 (11.8 ng/mg,3.96-104.83) vs. tG2 (0.87,0-10.1;P = 0.011) and vs. tG3 (2.46,0-6.94;P = 0.001). MV [5HT] was significantly different between groups (P = 0.033) namely between tG1(32.4 ng/mg,8.36-106.73) vs. tG3(3.59,0-28.26;P = 0.01). In conclusion, platelet [5HT] was elevated in healthy and MMVD CKCS compared to healthy non-CKCS. LV [5HT] was elevated in MMVD compared to DCM/ARVC or non-cardiac disease. MV [5HT] was elevated in MMVD compared to non-cardiac disease."
A novel point mutation in the β1-tubulin gene in asymptomatic macrothrombocytopenic Norfolk and Cairn Terriers. Maria Elena Gelain, Walter Bertazzolo, Giuseppina Tutino, Elena Pogliani, Francesco Cian, Mary K. Boudreaux. Vet. Clinical Pathology; Sept. 2014;43(3):317-321. Quote: "Background: An asymptomatic macrothrombocytopenia, pheno-typically similar to asymptomatic inherited macrothrombocytopenia in Cavalier King Charles Spaniels, was described in a group of Norfolk Terriers (NT) from Northern Italy, and isolated cases were also reported in Cairn Terriers (CT). Objectives: The purpose of this work was to evaluate for the presence of a genetic defect in the β1-tubulin gene in macrothrombocytopenic NT and CT. Methods: Samples from 20 healthy dogs (13 NT and 7 CT) were collected at different institutions in Italy (n = 8), United Kingdom (n = 3), and United States (n = 9). Genomic DNA was harvested from EDTA-anticoagulated blood and all coding areas and exon–intron splice sites in the gene encoding β1-tubulin were amplified and sequenced. Results: Twelve dogs (9 NT and 3 CT) showed a single nucleotide polymorphism (SNP) in exon 1 at nucleotide position 5 (G5A) that would result in the change of an arginine to a histidine at amino acid position 2 (R2H). Four dogs (3 NT and one Cairn Terrier) were heterozygous for the SNP, and 4 dogs (one Norfolk Terrier and 3 CT) matched the normal canine genome. Homozygous dogs for the SNP were macrothrombocytopenic with platelet counts ranging from 19,000 to 110,000/μL. Heterozygous and normal dogs had normal platelet counts and morphology. None had the CKCS point mutation. Conclusions: The β1-tubulin N-terminal amino acids form the nucleotide-binding domain and thus this mutation could affect GTP binding enough to influence platelet formation in homozygous but not in heterozygous dogs. The presence of macrothrombocytopenia only in homozygous affected dogs reveals an association between the SNP and the phenotype."
Pancreatitis in Cavaliers: What is it and what can I do about it? Penny Watson. Companion Cavalier Club Health Seminar. November 2014.DVD. Quote: "So the cavalier disease, we've been very lucky ... to be able to look at sections of pancreas now of over 40 cavalier King Charles spaniels, most of which were older but some of which were younger. So, we have an age range. ... What we've found, just looking at the histology, is that there is a very high prevalence, and that by the time we get to dogs of 11, 12, 13, I would be surprised to see a normal pancreas. And I would say the prevalence of chronic pancreatitis in cavaliers mimics mitral valve disease. ... I would say about 80%. ... Like mitral valve disease, it is a disease of aging. It is not so common in younger dogs. ... We had a theory that these dogs have an increased propensity to produce scar tissue, and that in fact they are doing it in multiple organs. So, there is so link between some of these diseases. ... When we look at the central nervous system in dogs with syringomyelia histologically, we find more fibrosis around blood vessels than you would normally find in a normal dog. ... We don't know what's causing the scarring in the pancreas. There is something causing it, and it seems to be coming up the ducts because that's where a lot of this is happening. And actually my theory at the moment is that it has something to do with the duct bacteria. And that theory has developed after seeing not one or two, but actually four or five cavaliers with chronic pancreatitis who respond very well to antibiotic therapy, metronidazole therapy specifically. And that's the sort of antibiotic that we use for overgrowth of bacteria in the small intestine, not the sort of antibiotic we use for other infections. And so I either think they've got gut bacteria coming up the duct, and perhaps their normal gut bacteria and it just that cavaliers' over-responding. Or, maybe there's something about their duct flora that's driving it, but I think there is a link there, somehow or another between the cavalier's gut flora and what's happening in the pancreas. Now why might they [cavaliers] be forming too much scar tissue? ... A current theory revolves around their platelets. Platelets are blood clotting cells. ... In cavaliers, about 50% of cavaliers in the UK have these macro-platelets, these jumbo platelets. ... Something in these cavaliers is stimulating these stellate cells to transform and produce lots of fibrous tissue. ... We noticed in cavaliers ... that there was a pattern of increased fibrosis in multiple organs, the kidneys particularly. Mitral valve disease isn't scarring. Mitral valve disease is myxomatous change. ... But the cells that produce that are valvular interstitial cells, and they are identical to the stellate cells in the pancreas. The current theory ... is that these little dogs might have something in their platelets that they are releasing when they are going through blood vessels into different organs that's tending to cause fibrosis. And our theory ... is that this might be serotonin, which is also known as 5-hydroxytryptamine, because platelets contain a bucket load of serotonin. ... We already know that some cavaliers have elevated levels of serotonin, that's been shown. We also already know that serotonin is central to converting those valvular interstitial cells into myofibroblasts. ... I think what was most compelling for me was the human side of it. There is a particular horrible syndrome in people called carcinoid syndrome. People who've got serotonin secreting tumors that they've got. ... They get pancreatic, liver, and kidney fibrosis and mitral valve disease. ... So in a nutshell, the hypothesis was these big floppy platelets release serotonin easily as they pass through vessels, leading to fibrosis in perivascular areas."
Thrombocytopenia in a dog -- Getting the diagnosis correct.
Donna J. Spector. VCA Clinical Consults. What's Your Diagnosis? January
2015;7(1). Quote: "Hereditary Macrothrombocytopenia: Many types of
hereditary macrothrombocytopenia have been identified in humans and
these conditions are associated with clinical bleeding. In dogs, the
most well described hereditary macrothrombocytopenia is in the
Cavalier King Charles Spaniel (CKCS). In contrast to people,
affected CKCS dogs have no evidence of clinical
bleeding and do not seem to have bleeding tendencies. Affected dogs
typically have larger than normal platelets and platelet numbers range
between 50,000-100,000/uL. Automated laboratory CBC analyzers may
underestimate platelet counts in affected dogs. Manual platelet counts
may give a more accurate platelet number and mean platelet volume (MPV;
average size of platelets) and plateletcrit (PCT; relative volume of
platelets) are useful parameters in accurately evaluating dogs affected
by macrothrombocytopenia. The disorder is characterized by an autosomal
recessive mode of inheritance and is very prevalent within CKCS
dogs in the United States. In 2007, the defect responsible for this
inherited macrothrombcytopenia was identified as a mutation present in
the gene that encodes β-1 tubulin. In normal unaffected dogs, β-1
tubulin is a component of the microtubules within megakaryocytes and it
plays a role in the orderly fragmentation of platelets from the
cytoplasm of mega-karyocytes. In affected dogs, the mutation results in
microtubule instability which alters megakaryocyte platelet release. The
result is the release of larger platelets with abnormal microtubule
morphology. Generally low platelet counts (<100,000/uL) correlate with a
homozygous state for the β-1 tubulin mutation, intermediate platelet
counts (200,000/uL) correlate with a heterozygous state for the mutation
and higher platelet counts (>250,000/uL) correlate with being free from
the mutation. Since identification of this mutation in the CKCS,
the identical mutation has been documented in several other breeds of
dogs including: Standard Poodle, Chihuahua, Labrador retriever, Poodle,
English Toy Spaniel, Greyhound, Labradoodle, Shih Tzu, Maltese, Norfolk
terrier and Jack Russell terrier. Other breeds are very likely to have
this mutation as well. Inherited macrothrombocytopenia should be
suspected in ANY dog with a
persistently low platelet count that is
nonresponsive to treatment with antibiotics or steroids and has no
history or evidence of abnormal bleeding. A DNA test is available at
Auburn University to determine the presence
or absence of this
mutation."
Effects of castration on cortisol and serotonin levels in dogs: Correlations between hormones and behavior. Elin Larsson. Swedish Univ. of Ag. Sciences. February 2015. Quote: "How behavior in dogs is affected by castration is unclear but there are increasing numbers of castrated dogs in Sweden and a common reason for castration is the owner hoping for behavioral problems to decrease. To study if the concentrations of behaviorally associated hormones are changing after castration and if the changes correlates with alteration in behavior may contribute to more knowledge about how castration affect dogs. In this study, seven bitches and three male dogs [including a male cavalier King Charles spaniel] were studied before and until four weeks after castration by analyzing cortisol and serotonin levels in urinary samples and through behavioral questionnaires to the dog owners. Cortisol is an important stress hormone and the serotonin system is largely involved in mental well-being. Creatinine was also analyzed in purpose of calculating hormone levels as hormone and creatinine concentration ratios, to minimize urinary density affecting the hormone levels. The females had significantly lower cortisol levels after castration than before. Among the bitches, the serotonin levels tended to increase after castration. The male dogs were few in number and no obvious changes in hormone levels were shown. It was not possible to see any clear behavioral changes but the bitches showed tendencies to be more active, more playful and more willing to be close to their owners. In order to draw reliable conclusions about effects of castration on hormone levels in dogs and if there is connection with any changes in behavior, more studies with larger numbers of dogs and more detailed behavioral studies are needed. It would also be interesting to study hormone levels and behavior during a longer period of time after castration."
Plasma and serum serotonin concentrations and surface-bound platelet serotonin expression in Cavalier King Charles Spaniels with myxomatous mitral valve disease. Signe E. Cremer, Annemarie T. Kristensen, Maria J. Reimann, Nynne B. Eriksen, Stine F. Petersen, Clara B. Marschner, Inge Tarnow, Mark A. Oyama, Lisbeth H. Olsen. Amer. J. Vet. Research. June 2015;76(6):520-51. Quote: "Objective: To investigate serum and plasma serotonin concentrations, percentage of serotonin-positive platelets, level of surface-bound platelet serotonin expression (mean fluorescence intensity [MFI]), and platelet activation (CD62 expression) in platelet-rich plasma from Cavalier King Charles Spaniels with myxomatous mitral valve disease (MMVD). Animals: Healthy dogs (n = 15) and dogs with mild MMVD (18), moderate-severe MMVD (19), or severe MMVD with congestive heart failure (CHF; 10). Procedures: Blood samples were collected from each dog. Serum and plasma serotonin concentrations were measured with an ELISA, and surface-bound platelet serotonin expression and platelet activation were determined by flow cytometry. Results: Dogs with mild MMVD had higher median serum (746 ng/mL) and plasma (33.3 ng/mL) serotonin concentrations, compared with MMVD-affected dogs with CHF (388 ng/mL and 9.9 ng/mL, respectively), but no other group differences were found. Among disease groups, no differences in surface-bound serotonin expression or platelet activation were found. Thrombocytopenic dogs had lower serum serotonin concentration (482 ng/mL) than nonthrombocytopenic dogs (731 ng/mL). In 26 dogs, a flow cytometry scatterplot subpopulation (FSSP) of platelets was identified; dogs with an FSSP had a higher percentage of serotonin-positive platelets (11.0%), higher level of surface-bound serotonin expression (MFI, 32,068), and higher platelet activation (MFI, 2,363) than did dogs without an FSSP (5.7%, 1,230, and 1,165, respectively). An FSSP was present in 93.8% of thrombocytopenic dogs and in 29.5% of nonthrombocytopenic dogs. Conclusions and Clinical Relevance: A substantive influence of circulating serotonin on MMVD stages prior to CHF development in Cavalier King Charles Spaniels was not supported by the study findings. An FSSP of highly activated platelets with pronounced serotonin binding was strongly associated with thrombocytopenia but not MMVD."
In-Clinic Hematology: The Blood Film Review. Leslie Sharkey, Daniel Heinrich. Today's Vet. Prac. July 2015;43-53. Quote: "Platelets: Identification of platelet clumps, including visual estimation by examination of a blood film, is essential to verify the accuracy of automated platelet counts because technical problems can interfere with accurate platelet counting. Large platelets are evidence of platelet turnover, which can refl ect destructive or consumptive processes, such as immune-mediated thrombocytopenia, inflammation, and disseminated intravascular coagulation. Keep in mind that an expanding number of breeds have congenital macrothrombocytopenia initially characterized in Cavalier King Charles spaniels; these breeds include Norfolk and Cairn terriers, Chihuahuas, Labrador retrievers, poodles, English toy spaniels, shih tzus, Maltese, Jack Russell terriers, Havanese, boxers, cocker spaniels, bichons frises, and some mixed breeds. Due to the fact that the platelet mass in these breeds appears to be relatively normal, with platelet size compensating for the low number of platelets, clinical bleeding is not a characteristic of the syndrome. Presence of persistent moderate thrombocytopenia, appearance of large platelets, and lack of history of unusual bleeding likely indicates this syndrome. When a plateletcrit is available, it should be normal or just below the reference interval. Genetic testing can be performed at Auburn University to confirm this diagnosis in breeds in which this genetic mutation has been characterized."
Canine Primary (Idiopathic) Immune-Mediated Thrombocytopenia. Marie Chartier. Clinician's Brief. September 2015:82-86.
Evaluation of whole blood hemostasis with thromboelastography in Cavalier King Charles spaniels with different severities of myxomatous mitral valve disease. J. Öberg, I. Lilliehöök, K. Höglund, I. Ljungvall. Vet. Clinical Pathology. July 2016. Quote: Background: Previous studies investigating hemostatic function in Cavalier King Charles spaniel (CKCS) dogs with different severities of myxomatous mitral valve disease (MMVD) have shown divergent results. Macrothrombocytosis, commonly seen in CKCS, is possibly affecting the hemostatic function. Objective: Investigate potential associations between thromboelastographic (TEG) variables (R, angle, K, MA, G) and dog characteristics, echocardiographic variables, heart rate, systolic blood pressure, and presence of macrothrombocytosis in CKCS. Methods: A total of 50 prospectively recruited client-owned CKCS dogs were evaluated by echocardiography and classified into healthy, mild, and moderate to severe MMVD groups. Blood samples were analyzed using TEG and hematology analyzers. Macrothrombocytosis assessment was based on mean platelet volume. Results: No differences were detected between MMVD severity groups and TEG variables. Unilinear regression analyses showed that left ventricular (LV) fractional shortening (FS%) increased with decreasing TEG K (r² = .23, P = .0004), and TEG R (r² = .09,P= .041), and with increasing angle (r² = .22, P = .0006), MA (r² = .13, P = .01) and G (r² = .15, P = .0067). Associations between LV FS% and TEG variables were confirmed in the multiple regression analysis. Macro-thrombocytosis was associated with increased TEG MA and G. An association between increasing age and a more hypercoagulable pattern was demonstrated by TEG variables. Conclusions and Clinical Importance: Increased LV FS%, macrothrombocytosis, and age were shown to be associated with a more activated hemostasis, which might have an implication in MMVD progression in CKCS.
Platelet function and activation in Cavalier King Charles Spaniels with subclinical chronic valvular heart disease. Linda J. Tong, Giselle L. Hosgood, Anne T. French, Peter J. Irwin, Robert E. Shie. Amer. J. Vet. Res. August 2016;77(8):860-868. Quote: Objective: To assess platelet closure time (CT), mean platelet component (MPC) concentration, and platelet component distribution width (PCDW) in dogs with subclinical chronic valvular heart disease. Animals: 89 Cavalier King Charles Spaniels (CKCSs) and 39 control dogs (not CKCSs). Procedures: Platelet count, MPC concentration, PCDW, and Hct were measured by use of a hematology analyzer, and CT was measured by use of a platelet function analyzer. Murmur grade and echocardiographic variables (mitral valve regurgitant jet size relative to left atrial area, left atrial-to-aortic diameter ratio, and left ventricular internal dimensions) were recorded. Associations between explanatory variables (sex, age, murmur grade, echocardiographic variables, platelet count, and Hct) and outcomes (CT, MPC concentration, and PCDW) were examined by use of multivariate regression models. Results: A model with 5 variables best explained variation in CT (R2, 0.74), with > 60% of the variance of CT explained by mitral valve regurgitant jet size. The model of best fit to explain variation in MPC concentration included only platelet count (R2, 0.24). The model of best fit to explain variation in PCDW included platelet count and sex (R2, 0.25). Conclusions and Clinical Relevance: In this study, a significant effect of mitral valve regurgitant jet size on CT was consistent with platelet dysfunction. However, platelet activation, as assessed on the basis of the MPC concentration and PCDW, was not a feature of subclinical chronic valvular heart disease in CKCSs. (See also this 2017 thesis.)
Frequency estimation of disease-causing mutations in the Belgian population of some dog breeds - Part 2: retrievers and other breed types. E. Beckers, M. Van Poucke, L. Ronsyn, L. Peelman. Vlaams Diergeneeskundiig Tijdschrift. October 2016:185-196. Quote: A Belgian population of ten breeds with a low to moderately low genetic diversity or which are relatively popular in Belgium, i.e. Bichon frise, Bloodhound, Bouvier des Flandres, Boxer, Cavalier King Charles spaniel, Irish setter, Papillon, Rottweiler, Golden retriever and Labrador retriever, was genotyped for all potentially relevant disease-causing variants known at the start of the study. In this way, the frequency was estimated for 26 variants in order to improve breeding advice. Disorders with a frequency high enough to recommend routine genotyping in breeding programs are (1) degenerative myelopathy for the Bloodhound, (2) arrhythmogenic right ventricular cardiomyopathy and degenerative myelopathy for Boxers, (3) episodic falling syndrome and macrothrombocytopenia for the Cavalier King Charles spaniel, (4) progressive retinal atrophy rod cone dysplasia 4 for the Irish setter (5) Golden retriever progressive retinal atrophy 1 for the Golden retriever and (6) exercise induced collapse and progressive rod-cone degeneration for the Labrador retriever. To the authors’ knowledge, in this study, the presence of a causal mutation for a short tail in the Bouvier des Flandres is described for the first time. ... Macrothrombocytopenia (MTC) is an autosomal intermediate inheriting trait in the Cavalier King Charles spaniel. Animals with this mutation have a shortage of platelets and may potentially develop problems in the primary hemostasis. Heterozygotes have less thrombocytes than homozygous normal animals, but homozygous mutant animals have an even bigger shortage. This disorder is not a disease per se, since affected animals do not usually have bleeding tendencies. The main problem is situated in unnecessary treatments with antibiotics or corticosteroids, which are often given because of the abnormal blood parameters (Davis et al., 2008). In the genotyped population of the Cavalier King Charles spaniel of this study, a large mutant allele frequency of 46.6% was estimated (15.9% homozygous mutant and 41.4% heterozygous dogs) (Table 3). This is similar to the one found by Davis et al. (2008). They genotyped a Dublin population (n = 40) and found 12.5% homozygous mutants and 52.5% heterozygotes. In the same study, an even larger percentage (47.0% homozygous mutant and 45.0% heterozygous dogs) was found in a USA population (n = 60). In view of the very high percentage, the authors recommend routine genotyping in all dogs in order to prevent wrongful medicinal use. ... A very high frequency was found for MTC in the Cavalier King Charles spaniel (q = 46.6%). The lack of symptoms may partly explain the high frequency. Another hypothesis is that the causal mutation is closely linked to a positive quality, thus selecting in favor of the MTC mutation, but this has yet to be tested. ... Macrothrombocytopenia should be tested in all Cavalier King Charles spaniels. Heterozygotes for these mutations and even homozygotes for the less severe disorders should not be routinely excluded from breeding programs, since this may lead to an even more important decrease in genetic diversity of breeds with an already (relatively) small genetic basis. Instead, the results of the genotyping should be used to make a well-reasoned partner choice.
Top 5 Breed-Associated Hematologic Abnormalities. Heather A. Kridel. Clinicians Brief. October 2016. Quote: Inherited Macrothrombocytopenia in Cavalier King Charles Spaniels. Autosomally inherited macrothrombocytopenia is common in Cavalier King Charles spaniels. One study reported either homozygous or heterozygous mutations in the gene that encodes β1-tubulin in 81/100 Cavalier King Charles spaniels. Affected (ie, homozygous) dogs typically exhibit a decreased total platelet count ranging from 30 000 to 100 000/μL; carrier (ie, heterozygous) dogs exhibit a platelet count from ≈100 000 to 250 000 (range, 200 000-500 000/μL).2 Thrombocytopenia in heterozygous and homozygous dogs, however, is not associated with clinical bleeding, likely because the platelet function is normal and total platelet mass (ie, plateletcrit) is not decreased. Macrothrombocytes are platelets that are as large as or larger than erythrocytes in diameter (Figure 1, previous page).2 Because automated hematology analyzers that use impedance technology cannot distinguish these large platelets from erythrocytes, the automated platelet count may be much lower than the actual count. Performing a platelet count via hemocytometer or a platelet estimate on a blood smear may be more accurate for evaluation of true platelet count. It is important to recognize this breed-associated abnormality so these patients are not presumed to have thrombocytopenia associated with more severe underlying disease (eg, immune-mediated thrombocytopenia).
Inherited Macrothrombocytopenia in a Cavalier King Charles Spaniel. Hyo-jin Kim, Seok-jin Choi, Seung-Gon Kim, Hee-Myung Park. J. Vet. Clinics. September 2017;34(4):272-274. Quote: A 1-year-old intact male Cavalier King Charles Spaniel was presented with a ruptured anal sac. On routine preanesthetic screening tests for surgical resection, the thrombocytopenia was observed by an impedance-type autoanalyzer. A peripheral blood smear was used as a follow-up test and giant platelets were seen on the smear. DNA assay of this patient confirmed that the cause of the platelet abnormalities in this patient was genetic mutation. To our knowledge, this is the first case report of macrothrombocytopenia confirmed based on the DNA assay results, in a Cavalier King Charles Spaniel in Korea.
Comparing the prevalence of pulmonary hypertension in Cavalier King Charles Spaniels and other breeds in dogs with myxomatous mitral valve disease. Siddharth Sudunagunta, Jo Dukes-McEwan. BSAVA Congress 2018 Proceedings. April 2018;p. 446. Quote: Objectives: To determine if Cavalier King Charles spaniels (CKCS) are more likely to develop pulmonary hypertension (PH) as a result of myxomatous mitral valve disease (MMVD) than dogs of other breeds and also assess whether PH impacts upon survival. A secondary objective was to explore any association between the presence of macroplatelets and PH. Methods: Retrospective review of 187 dogs diagnosed with MMVD identified from electronic patient records, 94 CKCS and 93 non-CKCS. Eligible dogs were >5 years of age, weighed <20 kg and had structural cardiac changes due to MMVD on echocardiography (nodular thickening of the mitral valve, dilated left atrium and ventricle) with or without congestive heart failure (CHF). Data retrieved were analysed for the presence of PH (based on tricuspid regurgitation velocity >2.8 m/s), CHF, selected echocardiographic variables and macroplatelets. Survival analysis was also performed, on both cardiac and all-cause mortality. Results: 71/94 CKCS and 52/93 non-CKCS developed PH (p=0.005). 57/94 CKCS and 45/93 non-CKCS were in left-sided CHF (p=0.093). PH was associated with a greater likelihood of CHF (p<0.001) and death (both cardiac (p<0.001) and all-cause mortality (p=0.011)). CKCS were more likely to experience cardiac death than non-CKCS (p=0.004). Macroplatelets were not associated with PH development (p=0.376). Conclusions: CKCS were more likely than non-CKCS to develop PH due to MMVD in this study population. Further investigations are required to determine the reason for this. Macroplatelets were not associated with the development of PH.
Platelet indices and their association with chronic valvular heart
disease in Cavalier King Charles spaniels.
Linda J Tong. Murdoch Univ. thesis. May 2018. Quote: Chronic valvular
heart disease (CVHD) is common in Cavalier King Charles spaniel
(CKCS) and has the potential to affect platelet activation or
function. The present study objective was to determine platelet closure
time, mean platelet component (MPC) concentration and platelet component
distribution
 width (PCDW) in dogs with subclinical CVHD, and to assess
the factors influencing these variables. A second objective was to
assess platelet count, MPC concentration, PCDW, mean platelet volume
(MPV), platelet volume distribution width (PDW), plateletcrit (PCT),
mean platelet mass (MPM) and platelet mass distribution width (PMDW) in
CKCS. Haematological values, closure time, murmur grade
and echocardiographic variables were recorded in 89 CKCS.
Associations between explanatory variables (sex, age, murmur grade,
echocardiographic variables, platelet count, and haematocrit (HCT)) and
outcomes (closure time, MPC concentration, and PCDW) were examined using
multivariate regression analysis. Platelet indices were compared between
CKCS and a group of 39 control dogs (non-CKCS). A model
with 5 variables best explained variation in closure time (R2, 0.74),
with greater than 60% of the variance of closure time explained by
mitral valve regurgitant jet size. The model of best fit to explain
variation in MPC concentration included only platelet count (R2, 0.24).
The model of best fit to explain variation in PCDW included platelet
count and sex (R2, 0.25). The MPC concentration, MPV, PDW, MPM and PMDW
values were significantly higher, and the platelet count, PCT, PCDW and
HCT values significantly lower, in the CKCS compared to
control dogs. In the present study, a significant effect of mitral valve
regurgitant jet size on closure time was consistent with platelet
dysfunction. However, platelet activation, as determined by MPC
concentration and PCDW, was not a feature of subclinical CVHD in
CKCS. (See also this
August 2016 article.)
width (PCDW) in dogs with subclinical CVHD, and to assess
the factors influencing these variables. A second objective was to
assess platelet count, MPC concentration, PCDW, mean platelet volume
(MPV), platelet volume distribution width (PDW), plateletcrit (PCT),
mean platelet mass (MPM) and platelet mass distribution width (PMDW) in
CKCS. Haematological values, closure time, murmur grade
and echocardiographic variables were recorded in 89 CKCS.
Associations between explanatory variables (sex, age, murmur grade,
echocardiographic variables, platelet count, and haematocrit (HCT)) and
outcomes (closure time, MPC concentration, and PCDW) were examined using
multivariate regression analysis. Platelet indices were compared between
CKCS and a group of 39 control dogs (non-CKCS). A model
with 5 variables best explained variation in closure time (R2, 0.74),
with greater than 60% of the variance of closure time explained by
mitral valve regurgitant jet size. The model of best fit to explain
variation in MPC concentration included only platelet count (R2, 0.24).
The model of best fit to explain variation in PCDW included platelet
count and sex (R2, 0.25). The MPC concentration, MPV, PDW, MPM and PMDW
values were significantly higher, and the platelet count, PCT, PCDW and
HCT values significantly lower, in the CKCS compared to
control dogs. In the present study, a significant effect of mitral valve
regurgitant jet size on closure time was consistent with platelet
dysfunction. However, platelet activation, as determined by MPC
concentration and PCDW, was not a feature of subclinical CVHD in
CKCS. (See also this
August 2016 article.)
Analytical variability of estimated platelet counts on canine blood smears. Saverio Paltrinieri, Veronica Paciletti, Jari Zambarbieri. Vet. Clinic. Pathol. June 2018;47(2):197-204. Quote: Background: The analytical variability of estimated platelet counts in dogs has not been reported. Objectives: The purpose of this study was to assess the magnitude of analytical imprecision of platelet estimates and the possible impact of this imprecision on clinical decisions. Methods: Three independent observers counted the number of platelets in 3 different areas (LE = lateral edge; CM = central monolayer; FE = feathered edge) of 30 canine blood smears with different instrumental platelet counts. The coefficient of variation (CV) for each observer was calculated in different areas of each smear (intra‐observer variability), among different regions of each smear (inter‐area variability), and among different observers in each area (inter‐observer variability). The influence of these variabilities on the classification of platelet estimates as adequate, increased, or decreased was also assessed. Results: The CVs recorded in the different areas by each observer ranged from 8% to 88% and were negatively correlated (P < .001, r = −.65) with the mean number of platelets per field. The mean platelet number was significantly lower in the FE and significantly higher in the CM compared with the LE, but the magnitude of this difference varied with the operators. The concordance among operators regarding platelet estimates was fair (k = 0.36) to substantial (k = 0.71) depending on the area. The overall inter‐area concordance was moderate (k = 0.59). Conclusions: ... The results of this study show that the intrinsic variability of the platelet estimate is high, operator-dependent, and influenced by the area of the smear. ... The immediate consequence of the different sources of variability listed above is that the platelet estimate determined by different observers could lead to a different classification (thrombocytopenic or not) of the same case. ... In summary, this study showed that the platelet estimate alone is not sufficiently precise to allow a reliable evaluation of platelet mass. ... This information should encourage the establishment and release of guidelines to standardize methods to perform reliable platelet estimates. In the absence of guidelines, it is prudent to be aware of platelet count estimate imprecision; and therefore, canine thrombogram evaluation should be based on a combination of hematology analyzer data, including platelet number, platelet size, and platelecrit, and microscopic evaluation including platelet morphology, the presence of platelet clumps and macroplatelets, and the platelet count estimate.
Urine 5-hydroxyindoleacetic acid in Cavalier King Charles spaniels with preclinical myxomatous mitral valve disease. L.B.Christiansen, S.E.Cremer, A. Helander, Tine Madsen, M.J. Reimann, J.E. Møller, K. Höglund, I. Ljungvall, J. Häggström, L. Høier Olsen. Vet. J. June 2019; DOI: 10.1016/j.tvjl.2019.06.005 Quote: Higher concentrations of circulating serotonin have been reported in Cavalier King Charles spaniels (CKCS) compared to other dog breeds. The CKCS is also a breed highly predisposed to myxomatous mitral valve disease (MMVD). The aim of this study was to determine urine concentrations of 5-hydroxyindoleacetic acid (5-HIAA), the major metabolite and excretion product of serotonin, in a population of CKCS with preclinical MMVD, and to evaluate whether urine 5-HIAA concentrations were associated with MMVD severity, dog characteristics, setting for urine sampling, platelet count, and serotonin concentration in serum and platelet-poor plasma (PPP). The study population consisted of 40 privately-owned CKCS (23 females; 17 males) with and without preclinical MMVD as follows: American College of Veterinary Internal Medicine (ACVIM) group A (n=11), ACVIM group B1 (n=21) and ACVIM group B2 (n=8). Urine 5-HIAA concentrations were not significantly associated with preclinical MMVD disease, platelet count or circulating concentrations of serotonin (in serum and PPP; P>0.05). Females had higher 5-HIAA concentrations than males in morning urine collected at home (females, 3.1 [2.9-3.7] µmol/mmol creatinine [median and quartiles]; males, 1.7 [1.2-2.2] µmol/mmol creatinine; P=0.0002) and urine collected at the clinic (females, 3.5 [3.1-3.9] µmol/mmol creatinine; males, 1.6 [1.3-2.1] µmol/mmol creatinine; P<0.0001). Five-HIAA concentrations in urine collected at home and at the clinic were significantly associated (P=0.0004; r=0.73), and higher concentrations were found in urine collected at the clinic (P=0.013). Urine 5-HIAA concentration was influenced by sex and setting of urine sampling. Urine 5-HIAA concentration was not associated with MMVD severity or circulating concentrations of serotonin in CKCS with preclinical disease. Highlights: •Urine 5-hydroxyindoleacetic acid (5-HIAA) concentrations predict progression of cardiac disease in some human conditions. •Urine 5-HIAA was measured in cavalier King Charles spaniels (CKCS) with preclinical myxomatous mitral valve disease (MMVD). •Urine 5-HIAA concentrations were higher in clinic-collected samples than in morning, home-collected samples. •Female CKCS showed higher urine 5-HIAA concentrations than male dogs. •Urine 5-HIAA concentrations were not associated with disease severity in CKCS with preclinical MMVD.
Hemostatic function in Cavalier King Charles Spaniels assessed using thromboelastography. Josefine Öberg, Inger Lilliehöö, Katja Höglund, Ingrid Ljungvall. Vet. Clin. Pathol. October 2019; doi: 10.1111/vcp.12795. Quote: Background: Macrothrombocytopenia is a well-known anomaly in Cavalier King Charles Spaniels (CKCSs), a breed also highly predisposed to develop myxomatous mitral valve disease (MMVD). Thromboelastography (TEG) has been shown to be a valuable instrument for whole blood hemostatic evaluation in dogs and correlates well with different physiologic and pathologic situations. Objectives: We aimed to assess the influence of macrothrombocytopenia and the severity of MMVD on hemostatic function as measured by TEG. Methods: Associations between TEG variables (R, K, α, MA, and G) and dog characteristics, heart rates, systolic blood pressures, MMVD severities (healthy, mild or moderate, and severe), echocardiographic variables, platelet variables (platelet count, mean platelet volume [MPV], and plateletcrit), and hematocrits were evaluated in 47 prospectively recruited privately owned CKCSs. Blood samples were analyzed using a computerized thromboelastograph and an Advia 2120 hematology analyzer. Results: Univariable and multiple regression analyses showed an effect of left ventricular (LV) fractional shortening (FS%) on all TEG variables, an effect of LV FS% and age on TEG α, and an effect of LV FS% and MPV on TEG MA and TEG G. TEG MA and G increased with increasing MPV, but the associations were generally weak. No significant differences were detected in the TEG variables between the MMVD severity groups. Conclusion: Macrothrombocytopenia and increased LV FS%, of which the latter commonly increases in various positive inotropic states, were both associated with a more hypercoagulable hemostatic system, according to the TEG results, in the present study.
The use of high-dose immunoglobulin M-enriched human immunoglobulin in dogs with immune-mediated hemolytic anemia. Jason P. Bestwick, Mellora Sharman, Nat T. Whitley, Caroline Kisielewicz, Barbara J. Skelly, Simon Tappin, Lindsay Kellett-Gregory, Mayank Seth. J. Vet. Intern. Med. November 2021; doi: 10.1111/jvim.16315. Quote: Background: The IV use of human immunoglobulin (hIVIG) in dogs with primary immune-mediated hemolytic anemia (IMHA) has been described previously, but herein we describe the use of high-dose IgM-enriched hIVIG (Pentaglobin). Hypothesis/Objectives: Dogs treated with high-dose Pentaglobin will experience shorter time to remission and hospital discharge and have decreased transfusion requirements compared to dogs receiving standard treatment alone. Animals: Fourteen client-owned dogs [including one Cavalier King Charles Spaniel] diagnosed with primary IMHA at specialist referral hospitals in the United Kingdom. Methods: All prospectively enrolled dogs received prednisolone, dexamethasone or both along with clopidogrel. Patients were randomized to receive Pentaglobin at 1 g/ kg on up to 2 occasions, or to serve as controls. No additional immunosuppressive drugs were allowed within the first 7 days of treatment. Remission was defined as stable PCV for 24 hours followed by an increase in PCV. Results: Ten of 11 dogs from the treatment group and 2 of 3 dogs from the control group achieved remission and survived until hospital discharge. Survival and time to remission were not significantly different between groups. The volume of packed red blood cells transfused, normalized for body weight, was not significantly different between groups. Potential adverse reactions to Pentaglobin occurred in 2 dogs, but their clinical signs may have been related to the underlying disease. ... The second dog was prescribed azathioprine on study day 26 because of development of thrombocytopenia despite continued remission of the IMHA. This dog was a Cavalier King Charles Spaniel and had some macroplatelets observed on blood smear evaluation but, before the consistent findings of thrombocytopenia, normal platelet counts had been documented and, after the addition of azathioprine, thrombocytopenia resolved, leading to a presumptive diagnosis of immune-mediated thrombocytopenia. This patient achieved remission from IMHA (on study day 6) and hospital discharge, and was alive and in remission at study day 90. ... Conclusions and Clinical Importance: Treatment with high-dose Pentaglobin was well tolerated by dogs with primary IMHA but no significant advantage was found in this small study. Additional studies examining larger groups and subpopulations of dogs with primary IMHA associated with a poorer prognosis are warranted.
Clinical and epidemiological characteristics of severe fever with thrombocytopenia syndrome in dogs: an observational study in the Republic of Korea. Sun-Woo Han, Ye-In Oh, Ji-Min Rim, Yoon-Kyoung Cho, Dong-Hoo Kim, Jun-Gu Kang, Kyoung-Seong Choi, Joon-Seok Chae. Research Sq. Mapril 2022; doi: 10.21203/rs.3.rs-1550957/v1. Quote: Severe fever with thrombocytopenia syndrome (SFTS) is a [tick-borne] zoonotic disease with a high mortality rate for humans and cats. The clinical course and prognosis of SFTS in dogs remains unclear. In the present study, we investigated the clinical and epidemiological characteristics of SFTS virus (SFTSV) infection in dogs. All evaluated dogs [14 dogs infected with SFTS including 1 cavalier King Charles spaniel] exhibited an acute course and symptoms such as fever (57.1%), anorexia (57.1%), depression (42.9%), and vomiting (35.7%)[, diarrhea (21.4%), hematochezia (21.4%), hematuria (7.1%), tachypnea (7.1%), eyelid swelling (7.1%), and oral mucosal erosion (7.1%)]. Thrombocytopenia was observed in 45.5% dogs, while jaundice was not observed. C-reactive protein, alanine transaminase, and alkaline phosphatase were elevated in some cases. Viral clearance occurred within 6 to 26 days. Phylogenetic analysis revealed that the SFTSV sequences were consistent with viruses in the regions of the Republic of Korea. Given that dogs often live in close contact with humans, awareness of the clinical and epidemiological features of SFTS in dogs is crucial. Further large-scale studies are necessary to investigate SFTSV infection in dogs.
Case Report: Inherited Macrothrombocytopenia in a Cavalier King Charles Spaniel. Tzu-Yi Ma, Chih-Jung Kuo, Chih-Chung Chou, and Pin-Chen Liu. Taiwan Vet. J. March 2024; doi: 10.1142/S1682648524720028. Quote: A 11-month-old intact male Cavalier King Charles Spaniel (CKCS) dog was presented at the Teaching Hospital of National Chung Hsin University (NCHU-VMTH) due to thrombocytopenia without relevant clinical signs and no significant improvement after medication treatment. As per the complete blood profile, there was significant thrombocytopenia (platelet count 1–31 x 10³/µL) with mean platelet volume (MPV) ranging from 20.3 to 25.7 fl. Tests for Babesia canis, B. gibsoni, Ehrlichia canis and Anaplasma phagocytophilum yielded negative results. ... IMT was suspected by LAH; subsequently, a three-week course of steroid treatment was initiated. An initial dosage of prednisolone (0.2 mg/kg) was administrated every 12 h orally, accompanied by cobalaplex (0.027 mg/ kg, PO, BID) and famotidine (0.8 mg/kg, PO, BID). Higher dosage of prednisolone (0.54 mg/kg, PO, BID) had been prescribed in the second week due to no improvement in platelet counts, and doxycycline (5.4 mg/ kg, PO, BID), famotidine (0.8 mg/kg, PO, BID) and silymarin (10 mg/kg, PO, BID) were also prescribed. Prednisolone (0.94 mg/kg, PO, BID), doxycycline (8 mg/kg, PO, BID), famotidine (0.8 mg/kg, PO, BID) and silymarin (10 mg/kg, PO, BID) were administrated for the third week. The condition of thrombocytopenia became worse than before from the concentration of 31 K/µL to 10K/µL with anemia and leukocytosis additionally observed. Elevated ALT and ALP levels were also observed owing to the consistent use of steroids. Steroid treatment was discontinued because of worsening thrombocytopenia, elevated hepatic enzyme levels, anemia and leukocytosis. The patient was referred to the NCHU-VMTH for consultation for persistent thrombocytopenia which did not respond to medication. Clinical physical examinations, including inspection of mucosal membranes, palpation of lymph nodes and cardiac and lung auscultation, were performed regularly and revealed no abnormalities on the day the patient presented to NCHU-VMTH. No abnormalities were detected by abdominal radiography or ultrasonography. ... In this case, the patient had normal clotting times before neutering surgery, and blood typing was performed to ensure compatibility with potential transfusions. ... Despite treatment with antibiotics and immunosuppressive drugs, the dog's condition did not improve. ... In this case, the CKCS patient had markedly enlarged platelets and thrombocytopenia, along with leukocytosis, most likely attributable to infection following steroid immunosuppression. Leukocyte counts returned to normal and stabilized once steroid treatment was discontinued. ... Leukocytosis and worsening platelet count in this case may have been due to systemic infection related to steroid treatment. ... The dog's platelet morphology and absence of symptoms raised the suspicion of inherited macrothrombocytopenia. Genomic DNA sequencing analysis of the 1-tubulin gene revealed a single-point mutation, specifically c.745 G>A. This genetic analysis confirmed the presence of a 1-tubulin mutation, marking the first reported case of such a mutation in a CKCS in Taiwan. Despite the diagnosis of this condition, both partial thromboplastin time (PTT) and active partial thromboplastin time (aPTT) were within normal ranges before neutering. ... In summary, CKCS in this case exhibits autosomal recessive inherited macrothrombocytopenia with no bleeding abnormalities, increased platelet size, reduced platelet counts, normal aggregation responses and minimal clinical associations that all these ¯ndings are lining with the previous exam. The diagnosis in this case is more complicated than the previous studies because leukocytosis was also present simultaneously after the administration of immune-suppressive medication. The animal with severe in°ammation might also have thrombocytopenia. ... When diagnosing the causes of thrombocytopenia in young patients, especially when there are no related clinical signs, it is crucial to consider prioritizing inherited macro-thrombocytopenia, then thrombocytopenia secondary to parasite infection, or immune-mediated thrombocytopenia (IMT) to minimize unnecessary medication.
ACVIM consensus statement on the diagnosis of immune thrombocytopenia in dogs and cats. Dana N. LeVine, Linda Kidd, Oliver A. Garden, Marjory B. Brooks, Robert Goggs, Barbara Kohn, Andrew J. Mackin, Erin R. B. Eldermire, Yu-Mei Chang, Julie Allen, Peter W. Christopherson, Barbara Glanemann, Haruhiko Maruyama, Maria C. Naskou, Lise N. Nielsen, Sarah Shropshire, Austin K. Viall, Adam J. Birkenheuer, Marnin A. Forman, Andrew S. Hanzlicek, Kathrin F. Langner, Erin Lashnits, Katharine F. Lunn, Kelly M. Makielski, Xavier Roura, Eva Spada. J. Vet. Inern. Med. May 2-24; doi: 10.1111/jvim.16996. Quote: Immune thrombocytopenia (ITP) is the most common acquired primary hemostatic disorder in dogs. Immune thrombocytopenia less commonly affects cats but is an important cause of mortality and treatment-associated morbidity in both species. Immune thrombocytopenia remains a diagnosis of exclusion for which diagnostic guidelines are lacking. ... The clinical presentation of primary ITP is also variable, with limited association between thrombocytopenia severity and clinical signs of bleeding. Many dogs and cats remain subclinical despite severe thrombocytopenia, whereas others with similar platelet counts experience life-threatening hemorrhage.22 Biomarkers of disease severity are needed to guide individualized treatment. ... Primary, or non-associative, ITP refers to autoimmune platelet destruction. Secondary, or associative, ITP arises in response to an underlying disease trigger. However, evidence for which comorbidities serve as ITP triggers has not been systematically evaluated. To identify key diagnostic steps for ITP and important comorbidities associated with secondary ITP, we developed 12 Population Evaluation/Exposure Comparison Outcome (PECO) format questions. These questions were addressed by evidence evaluators utilizing a literature pool of 287 articles identified by the panelists using a structured search strategy. Evidence evaluators, using panel-designed templates and data extraction tools, summarized evidence and created guideline recommendations that then were integrated by diagnosis and comorbidity domain chairs. The revised PECO responses underwent a Delphi survey process to reach consensus on final guidelines. A combination of panel expertise and PECO responses were employed to develop algorithms for diagnosis of ITP in dogs and cats, which also underwent 4 iterations of Delphi review. Comorbidity evidence evaluators employed an integrated measure of evidence (IME) tool to determine evidence quality for each comorbidity; IME values combined with evidence summaries for each comorbidity were integrated to develop ITP screening recommendations, which also were subjected to Delphi review. Commentary was solicited from multiple relevant professional organizations before finalizing the consensus. The final consensus statement provides clinical guidelines for the diagnosis of, and underlying disease screening for, ITP in dogs and cats. The systematic consensus process identified numerous knowledge gaps that should guide future studies. This statement is a companion manuscript to the ACVIM Consensus Statement on the Treatment of Immune Thrombocytopenia. ... Although not included in our systematic review, we recommend that identification of macrothrombocytes, particularly in healthy dogs lacking signs of a primary hemostatic defect and breeds, or mixed breeds, with hereditary macrothrombocytopenia, should prompt genetic testing early in the diagnostic evaluation.


CONNECT WITH US